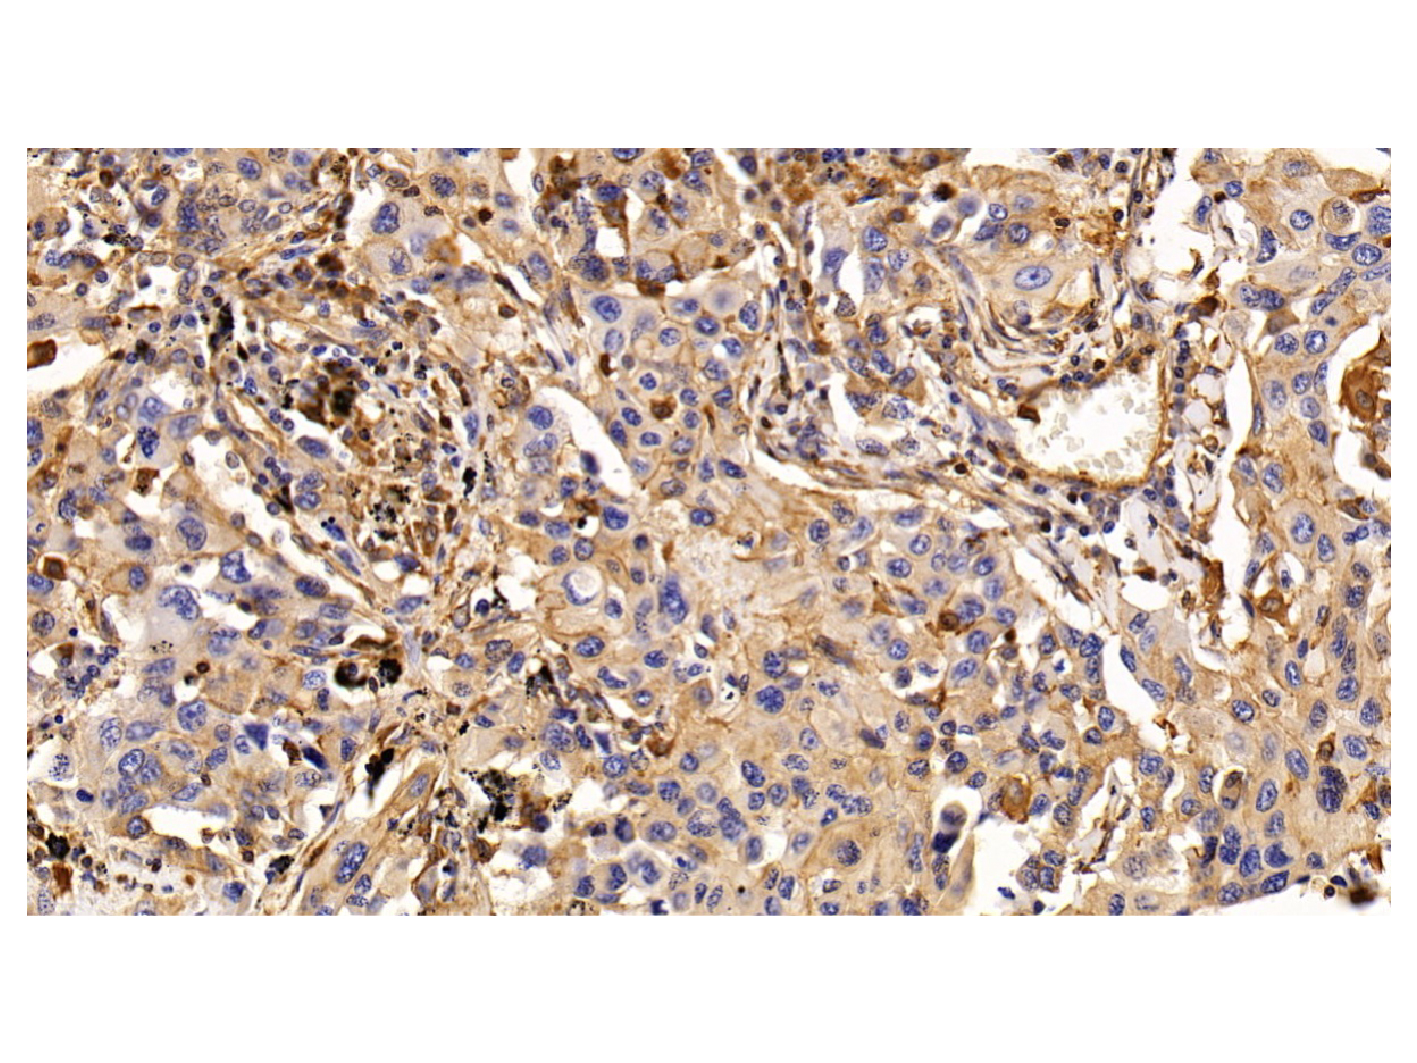
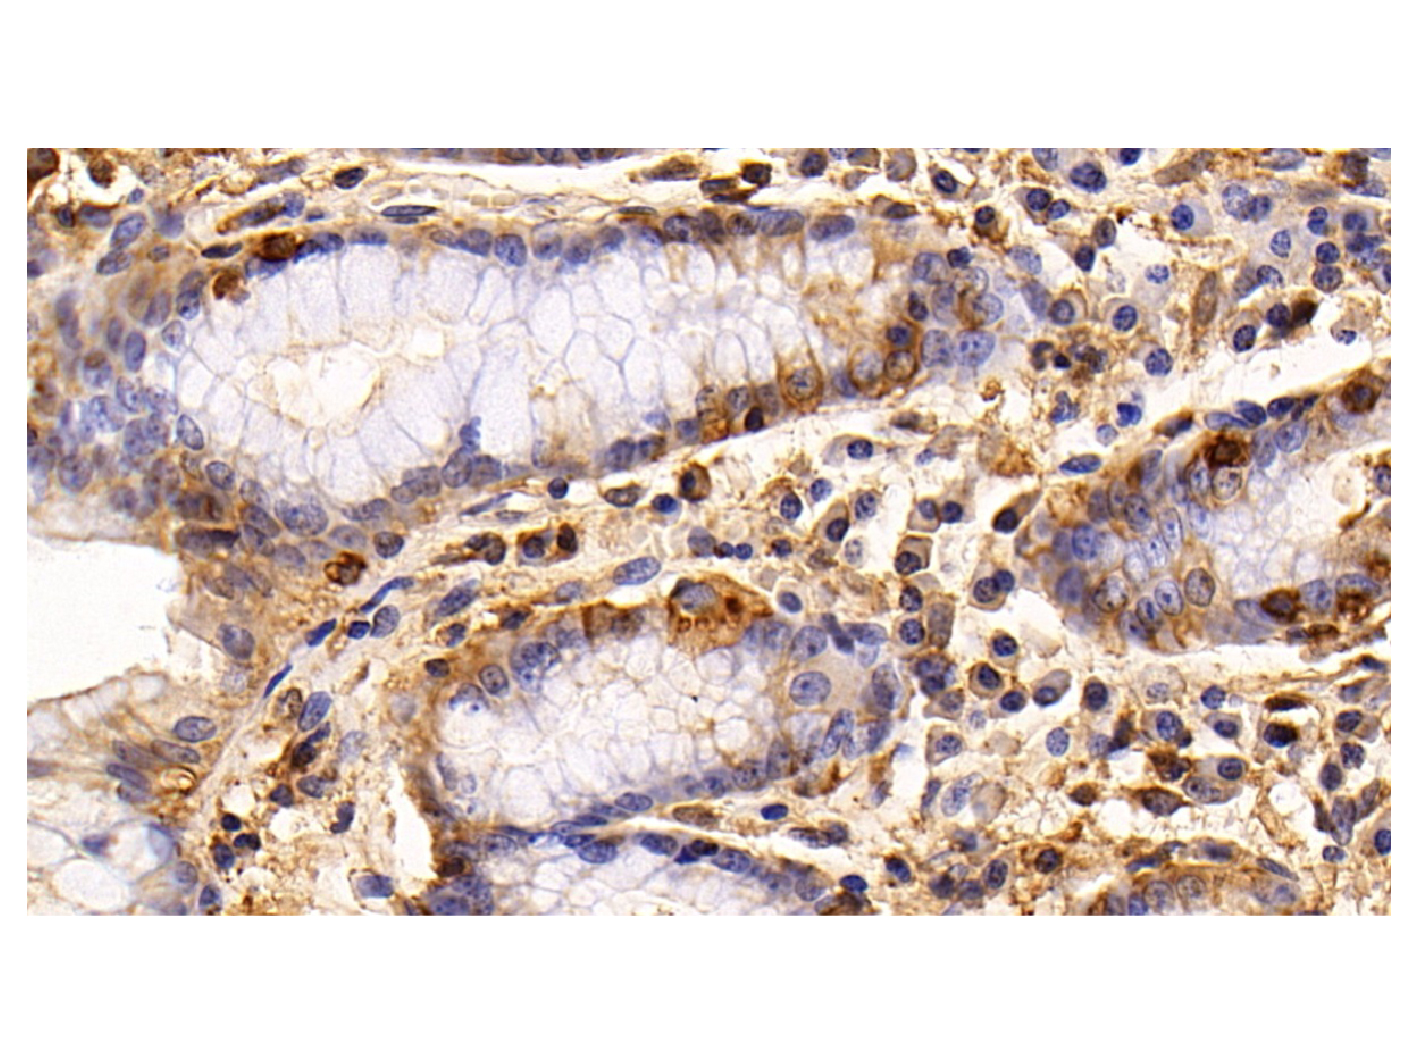

计算溶液所需的质量、体积或浓度。
This is a demo store. No orders will be fulfilled.

| 货号 (SKU) | 包装规格 | 是否现货 | 价格 | 数量 |
|---|---|---|---|---|
| Ab101163-10μl |
10μl |
现货  |
| |
| Ab101163-50μl |
50μL |
现货  |
| |
| Ab101163-100μl |
100μL |
现货  |
| |
| Ab101163-1ml |
1ml |
期货  |
|
| 产品名称 | EGFR Mouse mAb |
|---|---|
| 别名 | 表皮生长因子受体抗体 | 表皮生长因子受体单克隆抗体 | EGFR抗体 | EGFR单克隆抗体 |
| 英文别名 | ErbB-1 | ErbB1 | ER1 | ERB-B1 | MENA | HER1 | Erythroblastic Leukemia Viral(v-Erb-B)oncogene Homolog,Avian | Proto-oncogene c-ErbB-1 | Receptor tyrosine-protein kinase erbB-1 | Avian erythroblastic leukemia viral (v erb b) oncogene homolog antibody | Cell |
| 规格或纯度 | 无载体, ExactAb™, 已验证, 高性能, 见COA |
| 生化机理 | Receptor tyrosine kinase binding ligands of the EGF family and activating several signaling cascades to convert extracellular cues into appropriate cellular responses. Known ligands include EGF, TGFA/TGF-alpha, amphiregulin, epigen/EPGN, BTC/betacellulin, epiregulin/EREG and HBEGF/heparin-binding EGF. Ligand binding triggers receptor homo- and/or heterodimerization and autophosphorylation on key cytoplasmic residues. The phosphorylated receptor recruits adapter proteins like GRB2 which in turn activates complex downstream signaling cascades. Activates at least 4 major downstream signaling cascades including the RAS-RAF-MEK-ERK, PI3 kinase-AKT, PLCgamma-PKC and STATs modules. May also activate the NF-kappa-B signaling cascade. Also directly phosphorylates other proteins like RGS16, activating its GTPase activity and probably coupling the EGF receptor signaling to the G protein-coupled receptor signaling. Also phosphorylates MUC1 and increases its interaction with SRC and CTNNB1/beta-catenin. Isoform 2 may act as an antagonist of EGF action. |
| 宿主种属 | 小鼠(Mouse) |
| 特异性 | EGFR |
| 种属反应性 | 人(Human),小鼠(Mouse) |
| 免疫原 | Recombinant EGFR expressed in E.coli (AA 888-1210) |
| 阳性对照 | WB: A431, HeLa, MCF7, A549, NIH/3T3 and HUVEC cell lysates. IHC: Human kidney, placent, lung cancer, stomach, adrenal gland, liver cancer tissues. IF/ICC: HeLa cells. |
| 偶联 | Unconjugated |
| 克隆类型 | 单克隆抗体 |
|---|---|
| 克隆号 | C4 |
| Format | Whole IgG |
| 亚型 | IgG2b |
| 轻链亚型 | kappa |
| SDS-PAGE | 150 kDa |
| 纯化方法 | Protein A + Protein G purified |
| 物理外观 | Liquid |
| 储存缓冲液 | 10mM PBS, 50% Glycerol, 0.02% Sodium azide, pH7.4 |
| 防腐剂 | 0.02% Sodium azide |
| 浓度 | 见COA |
| 储存温度 | -20°C储存,避免反复冻融 |
| 运输条件 | 超低温冰袋运输 |
| 稳定性与储存 | 4°C 短期储存(1-2 周)。-20°C下长期保存(24个月)。收货后建议分装。避免冷冻/解冻循环。 |
| 分子类型 | 抗体 |
| 作用机制 | Action Type | target ID | Target Name | Target Type | Target Organism | Binding Site Name | 参考文献 |
|---|

EGFR Mouse mAb (Ab101163) - Western Blot
All lanes: EGFR Mouse mAb (Ab101163) at 1/1000 dilution
Samples: Lysates at 20 µg per lane
Secondary: Goat Anti-Mouse IgG H&L (HRP) (Ab138040) at 1/20000 dilution
Predicted band size: 175 kDa
Observed band size: 169 & 69 kDa
Exposure time: 10.4 s

EGFR Mouse mAb (Ab101163) - Western Blot
All lanes: EGFR Mouse mAb (Ab101163) at 1/1000 dilution
Samples: Lysates at 20 µg per lane
Secondary: Goat Anti-Mouse IgG H&L (HRP) (Ab138040) at 1/20000 dilution
Predicted band size: 175 kDa
Observed band size: 169 & 69 kDa
Exposure time: 2.3 s

EGFR Mouse mAb (Ab101163) - IHC
DAB staining on IHC
Sample: Human Kidney Tissue
Primary Ab: 5 μg/mL EGFR Mouse mAb (Ab101163)
Second Ab: 2 µg/mL HRP-Linked Caprine Anti-Mouse IgG Polyclonal Antibody.

EGFR Mouse mAb (Ab101163) - IHC
DAB staining on IHC
Sample: Human Placenta Tissue
Primary Ab: 5 μg/mL EGFR Mouse mAb (Ab101163)
Second Ab: 2 µg/mL HRP-Linked Caprine Anti-Mouse IgG Polyclonal Antibody.
EGFR Mouse mAb (Ab101163) - IHC
DAB staining on IHC
Sample: Human Lung cancer Tissue
Primary Ab: 5 μg/mL EGFR Mouse mAb (Ab101163)
Second Ab: 2 µg/mL HRP-Linked Caprine Anti-Mouse IgG Polyclonal Antibody.
EGFR Mouse mAb (Ab101163) - IHC
DAB staining on IHC
Sample: Human Stomach Tissue
Primary Ab: 5 μg/mL EGFR Mouse mAb (Ab101163)
Second Ab: 2 µg/mL HRP-Linked Caprine Anti-Mouse IgG Polyclonal Antibody.

EGFR Mouse mAb (Ab101163) - IHC
DAB staining on IHC
Sample: Human Adrenal gland Tissue
Primary Ab: 5 μg/mL EGFR Mouse mAb (Ab101163)
Second Ab: 2 µg/mL HRP-Linked Caprine Anti-Mouse IgG Polyclonal Antibody.

EGFR Mouse mAb (Ab101163) - IHC
DAB staining on IHC
Sample: Human Liver cancer Tissue
Primary Ab: 5 μg/mL EGFR Mouse mAb (Ab101163)
Second Ab: 2 µg/mL HRP-Linked Caprine Anti-Mouse IgG Polyclonal Antibody.
EGFR Mouse mAb (Ab101163) - IF/ICC
IF analysis of EGFR Mouse mAb (Ab101163) in HeLa cells. The cells were fixed and permeabilized with 100% methanol for 5 minutes, and blocked with 5% BSA for 1 hour at room temperature. Cells were stained with EGFR Mouse mAb (Ab101163) at 1/200 dilution in blocking buffer overnight at 4°C, and then incubated with Goat Anti-Mouse IgG H&L (FITC) (Ab179003) at a dilution of 1/1000 for 1 hour at room temperature in the dark (green). Cells were counterstained with DAPI (blue).
| 应用名称 | 稀释比例 |
|---|---|
| IHC | 5-20 µg/mL |
| WB |
0.01-2 µg/mL
|
| IF/ICC | 5 µg/mL |
通过匹配包装上的批号来查找并下载产品的 COA,每批产品都进行了严格的验证,您可放心使用!
| 批号(Lot Number) | 证书类型 | 货号 |
|---|---|---|
| 分析证书 | Ab101163 | |
| 分析证书 | Ab101163 | |
| 分析证书 | Ab101163 | |
| 分析证书 | Ab101163 | |
| 分析证书 | Ab101163 | |
| 分析证书 | Ab101163 | |
| 分析证书 | Ab101163 |

¥499.90

¥499.90
| 1. Revesz L, Di Padova FE, Buhl T, Feifel R, Gram H, Hiestand P, Manning U, Zimmerlin AG.. (2000) SAR of 4-hydroxypiperidine and hydroxyalkyl substituted heterocycles as novel p38 map kinase inhibitors.. Bioorg Med Chem Lett, 10 (11): (1261-1264). [PMID:10866395] [10.1016/s0960-894x(00)00200-6] |
| 2. Dumas J, Hatoum-Mokdad H, Sibley RN, Smith RA, Scott WJ, Khire U, Lee W, Wood J, Wolanin D, Cooley J, Bankston D, Redman AM, Schoenleber R, Caringal Y, Gunn D, Romero R, Osterhout M, Paulsen H, Housley TJ, Wilhelm SM, Pirro J, Chien DS, Ranges GE, Shrikhande A, Muzsi A, Bortolon E, Wakefield J, Gianpaolo Ostravage C, Bhargava A, Chau T.. (2002) Synthesis and pharmacological characterization of a potent, orally active p38 kinase inhibitor.. Bioorg Med Chem Lett, 12 (12): (1559-1562). [PMID:12039561] [10.1016/s0960-894x(02)00238-x] |
| 3. Showalter HD, Sercel AD, Leja BM, Wolfangel CD, Ambroso LA, Elliott WL, Fry DW, Kraker AJ, Howard CT, Lu GH, Moore CW, Nelson JM, Roberts BJ, Vincent PW, Denny WA, Thompson AM.. (1997) Tyrosine kinase inhibitors. 6. Structure-activity relationships among N- and 3-substituted 2,2'-diselenobis(1H-indoles) for inhibition of protein tyrosine kinases and comparative in vitro and in vivo studies against selected sulfur congeners.. J Med Chem, 40 (4): (413-426). [PMID:9046331] [10.1021/jm960689b] |
| 4. Rewcastle GW, Murray DK, Elliott WL, Fry DW, Howard CT, Nelson JM, Roberts BJ, Vincent PW, Showalter HD, Winters RT, Denny WA.. (1998) Tyrosine kinase inhibitors. 14. Structure-activity relationships for methylamino-substituted derivatives of 4-[(3-bromophenyl)amino]-6-(methylamino)-pyrido[3,4-d]pyrimidine (PD 158780), a potent and specific inhibitor of the tyrosine kinase activity of receptors for the EGF family of growth factors.. J Med Chem, 41 (5): (742-751). [PMID:9513602] [10.1021/jm970641d] |
| 5. Smaill JB, Palmer BD, Rewcastle GW, Denny WA, McNamara DJ, Dobrusin EM, Bridges AJ, Zhou H, Showalter HD, Winters RT, Leopold WR, Fry DW, Nelson JM, Slintak V, Elliot WL, Roberts BJ, Vincent PW, Patmore SJ.. (1999) Tyrosine kinase inhibitors. 15. 4-(Phenylamino)quinazoline and 4-(phenylamino)pyrido[d]pyrimidine acrylamides as irreversible inhibitors of the ATP binding site of the epidermal growth factor receptor.. J Med Chem, 42 (10): (1803-1815). [PMID:10346932] [10.1021/jm9806603] |
| 6. Liu K, Xu L, Szalkowski D, Li Z, Ding V, Kwei G, Huskey S, Moller DE, Heck JV, Zhang BB, Jones AB.. (2000) Discovery of a potent, highly selective, and orally efficacious small-molecule activator of the insulin receptor.. J Med Chem, 43 (19): (3487-3494). [PMID:11000003] [10.1021/jm000285q] |
| 7. Kim KS, Kimball SD, Misra RN, Rawlins DB, Hunt JT, Xiao HY, Lu S, Qian L, Han WC, Shan W, Mitt T, Cai ZW, Poss MA, Zhu H, Sack JS, Tokarski JS, Chang CY, Pavletich N, Kamath A, Humphreys WG, Marathe P, Bursuker I, Kellar KA, Roongta U, Batorsky R, Mulheron JG, Bol D, Fairchild CR, Lee FY, Webster KR.. (2002) Discovery of aminothiazole inhibitors of cyclin-dependent kinase 2: synthesis, X-ray crystallographic analysis, and biological activities.. J Med Chem, 45 (18): (3905-3927). [PMID:12190313] [10.1021/jm0201520] |
| 8. Hennequin LF, Stokes ES, Thomas AP, Johnstone C, Plé PA, Ogilvie DJ, Dukes M, Wedge SR, Kendrew J, Curwen JO.. (2002) Novel 4-anilinoquinazolines with C-7 basic side chains: design and structure activity relationship of a series of potent, orally active, VEGF receptor tyrosine kinase inhibitors.. J Med Chem, 45 (6): (1300-1312). [PMID:11881999] [10.1021/jm011022e] |
| 9. Kraker AJ, Hartl BG, Amar AM, Barvian MR, Showalter HD, Moore CW.. (2000) Biochemical and cellular effects of c-Src kinase-selective pyrido[2, 3-d]pyrimidine tyrosine kinase inhibitors.. Biochem Pharmacol, 60 (7): (885-898). [PMID:10974196] [10.1016/s0006-2952(00)00405-6] |
| 10. Huber K, Brault L, Fedorov O, Gasser C, Filippakopoulos P, Bullock AN, Fabbro D, Trappe J, Schwaller J, Knapp S et al.. (2012) 7,8-dichloro-1-oxo-β-carbolines as a versatile scaffold for the development of potent and selective kinase inhibitors with unusual binding modes.. J Med Chem, 55 (1): (403-13). [PMID:22136433] |
| 11. Ogiso H, Ishitani R, Nureki O, Fukai S, Yamanaka M, Kim JH, Saito K, Sakamoto A, Inoue M, Shirouzu M et al.. (2002) Crystal structure of the complex of human epidermal growth factor and receptor extracellular domains.. Cell, 110 (6): (775-87). [PMID:12297050] |
| 12. McHardy T, Caldwell JJ, Cheung KM, Hunter LJ, Taylor K, Rowlands M, Ruddle R, Henley A, de Haven Brandon A, Valenti M et al.. (2010) Discovery of 4-amino-1-(7H-pyrrolo[2,3-d]pyrimidin-4-yl)piperidine-4-carboxamides as selective, orally active inhibitors of protein kinase B (Akt).. J Med Chem, 53 (5): (2239-49). [PMID:20151677] |
| 13. Aertgeerts K, Skene R, Yano J, Sang BC, Zou H, Snell G, Jennings A, Iwamoto K, Habuka N, Hirokawa A et al.. (2011) Structural analysis of the mechanism of inhibition and allosteric activation of the kinase domain of HER2 protein.. J Biol Chem, 286 (21): (18756-65). [PMID:21454582] |
| 14. Kubo K, Shimizu T, Ohyama S, Murooka H, Iwai A, Nakamura K, Hasegawa K, Kobayashi Y, Takahashi N, Takahashi K et al.. (2005) Novel potent orally active selective VEGFR-2 tyrosine kinase inhibitors: synthesis, structure-activity relationships, and antitumor activities of N-phenyl-N'-{4-(4-quinolyloxy)phenyl}ureas.. J Med Chem, 48 (5): (1359-66). [PMID:15743179] |
| 15. Rabindran SK, Discafani CM, Rosfjord EC, Baxter M, Floyd MB, Golas J, Hallett WA, Johnson BD, Nilakantan R, Overbeek E et al.. (2004) Antitumor activity of HKI-272, an orally active, irreversible inhibitor of the HER-2 tyrosine kinase.. Cancer Res, 64 (11): (3958-65). [PMID:15173008] |
| 16. Zhou W, Ercan D, Chen L, Yun CH, Li D, Capelletti M, Cortot AB, Chirieac L, Iacob RE, Padera R et al.. (2009) Novel mutant-selective EGFR kinase inhibitors against EGFR T790M.. Nature, 462 (7276): (1070-4). [PMID:20033049] |
| 17. Adrián FJ, Ding Q, Sim T, Velentza A, Sloan C, Liu Y, Zhang G, Hur W, Ding S, Manley P et al.. (2006) Allosteric inhibitors of Bcr-abl-dependent cell proliferation.. Nat Chem Biol, 2 (2): (95-102). [PMID:16415863] |
| 18. Greenman C, Stephens P, Smith R, Dalgliesh GL, Hunter C, Bignell G, Davies H, Teague J, Butler A, Stevens C et al.. (2007) Patterns of somatic mutation in human cancer genomes.. Nature, 446 (7132): (153-8). [PMID:17344846] |
| 19. Sun L, Liang C, Shirazian S, Zhou Y, Miller T, Cui J, Fukuda JY, Chu JY, Nematalla A, Wang X et al.. (2003) Discovery of 5-[5-fluoro-2-oxo-1,2- dihydroindol-(3Z)-ylidenemethyl]-2,4- dimethyl-1H-pyrrole-3-carboxylic acid (2-diethylaminoethyl)amide, a novel tyrosine kinase inhibitor targeting vascular endothelial and platelet-derived growth factor receptor tyrosine kinase.. J Med Chem, 46 (7): (1116-9). [PMID:12646019] |
| 20. Lombardo LJ, Lee FY, Chen P, Norris D, Barrish JC, Behnia K, Castaneda S, Cornelius LA, Das J, Doweyko AM et al.. (2004) Discovery of N-(2-chloro-6-methyl- phenyl)-2-(6-(4-(2-hydroxyethyl)- piperazin-1-yl)-2-methylpyrimidin-4- ylamino)thiazole-5-carboxamide (BMS-354825), a dual Src/Abl kinase inhibitor with potent antitumor activity in preclinical assays.. J Med Chem, 47 (27): (6658-61). [PMID:15615512] |
| 21. Remsing Rix LL, Rix U, Colinge J, Hantschel O, Bennett KL, Stranzl T, Müller A, Baumgartner C, Valent P, Augustin M et al.. (2009) Global target profile of the kinase inhibitor bosutinib in primary chronic myeloid leukemia cells.. Leukemia, 23 (3): (477-85). [PMID:19039322] |
| 22. Gangjee A, Zhao Y, Ihnat MA, Thorpe JE, Bailey-Downs LC, Kisliuk RL. (2012) Novel tricyclic indeno[2,1-d]pyrimidines with dual antiangiogenic and cytotoxic activities as potent antitumor agents.. Bioorg Med Chem, 20 (14): (4217-25). [PMID:22739090] |
| 23. Manley PW, Furet P, Bold G, Brüggen J, Mestan J, Meyer T, Schnell CR, Wood J, Haberey M, Huth A et al.. (2002) Anthranilic acid amides: a novel class of antiangiogenic VEGF receptor kinase inhibitors.. J Med Chem, 45 (26): (5687-93). [PMID:12477352] |
| 24. Traxler P, Allegrini PR, Brandt R, Brueggen J, Cozens R, Fabbro D, Grosios K, Lane HA, McSheehy P, Mestan J et al.. (2004) AEE788: a dual family epidermal growth factor receptor/ErbB2 and vascular endothelial growth factor receptor tyrosine kinase inhibitor with antitumor and antiangiogenic activity.. Cancer Res, 64 (14): (4931-41). [PMID:15256466] |
| 25. Solca FF, Baum A, Langkopf E, Dahmann G, Heider KH, Himmelsbach F, van Meel JC. (2004) Inhibition of epidermal growth factor receptor activity by two pyrimidopyrimidine derivatives.. J Pharmacol Exp Ther, 311 (2): (502-9). [PMID:15199094] |
| 26. Barlaam B, Anderton J, Ballard P, Bradbury RH, Hennequin LF, Hickinson DM, Kettle JG, Kirk G, Klinowska T, Lambert-van der Brempt C et al.. (2013) Discovery of AZD8931, an Equipotent, Reversible Inhibitor of Signaling by EGFR, HER2, and HER3 Receptors.. ACS Med Chem Lett, 4 (8): (742-6). [PMID:24900741] |
| 27. Hennequin LF, Allen J, Breed J, Curwen J, Fennell M, Green TP, Lambert-van der Brempt C, Morgentin R, Norman RA, Olivier A et al.. (2006) N-(5-chloro-1,3-benzodioxol-4-yl)-7-[2-(4-methylpiperazin-1-yl)ethoxy]-5- (tetrahydro-2H-pyran-4-yloxy)quinazolin-4-amine, a novel, highly selective, orally available, dual-specific c-Src/Abl kinase inhibitor.. J Med Chem, 49 (22): (6465-88). [PMID:17064066] |
| 28. Katayama R, Khan TM, Benes C, Lifshits E, Ebi H, Rivera VM, Shakespeare WC, Iafrate AJ, Engelman JA, Shaw AT. (2011) Therapeutic strategies to overcome crizotinib resistance in non-small cell lung cancers harboring the fusion oncogene EML4-ALK.. Proc Natl Acad Sci USA, 108 (18): (7535-40). [PMID:21502504] |
| 29. Ballou LM, Selinger ES, Choi JY, Drueckhammer DG, Lin RZ. (2007) Inhibition of mammalian target of rapamycin signaling by 2-(morpholin-1-yl)pyrimido[2,1-alpha]isoquinolin-4-one.. J Biol Chem, 282 (33): (24463-70). [PMID:17562705] |
| 30. Huang H, Jia Q, Ma J, Qin G, Chen Y, Xi Y, Lin L, Zhu W, Ding J, Jiang H et al.. (2009) Discovering novel quercetin-3-O-amino acid-esters as a new class of Src tyrosine kinase inhibitors.. Eur J Med Chem, 44 (5): (1982-8). [PMID:19041163] |
| 31. Klutchko SR, Zhou H, Winters RT, Tran TP, Bridges AJ, Althaus IW, Amato DM, Elliott WL, Ellis PA, Meade MA et al.. (2006) Tyrosine kinase inhibitors. 19. 6-Alkynamides of 4-anilinoquinazolines and 4-anilinopyrido[3,4-d]pyrimidines as irreversible inhibitors of the erbB family of tyrosine kinase receptors.. J Med Chem, 49 (4): (1475-85). [PMID:16480284] |
| 32. Zhang P, Hu HR, Huang ZH, Lei JY, Chu Y, Ye DY. (2012) Identification of novel scaffold of benzothiazepinones as non-ATP competitive glycogen synthase kinase-3β inhibitors through virtual screening.. Bioorg Med Chem Lett, 22 (23): (7232-6). [PMID:23099099] |
| 33. Changelian PS, Moshinsky D, Kuhn CF, Flanagan ME, Munchhof MJ, Harris TM, Whipple DA, Doty JL, Sun J, Kent CR et al.. (2008) The specificity of JAK3 kinase inhibitors.. Blood, 111 (4): (2155-7). [PMID:18094329] |
| 34. Szczepankiewicz BG, Kosogof C, Nelson LT, Liu G, Liu B, Zhao H, Serby MD, Xin Z, Liu M, Gum RJ et al.. (2006) Aminopyridine-based c-Jun N-terminal kinase inhibitors with cellular activity and minimal cross-kinase activity.. J Med Chem, 49 (12): (3563-80). [PMID:16759099] |
| 35. Oyarzabal J, Zarich N, Albarran MI, Palacios I, Urbano-Cuadrado M, Mateos G, Reymundo I, Rabal O, Salgado A, Corrionero A et al.. (2010) Discovery of mitogen-activated protein kinase-interacting kinase 1 inhibitors by a comprehensive fragment-oriented virtual screening approach.. J Med Chem, 53 (18): (6618-28). [PMID:20722422] |
| 36. Fry DW, Bridges AJ, Denny WA, Doherty A, Greis KD, Hicks JL, Hook KE, Keller PR, Leopold WR, Loo JA et al.. (1998) Specific, irreversible inactivation of the epidermal growth factor receptor and erbB2, by a new class of tyrosine kinase inhibitor.. Proc Natl Acad Sci USA, 95 (20): (12022-7). [PMID:9751783] |
| 37. Gavrin LK, Green N, Hu Y, Janz K, Kaila N, Li HQ, Tam SY, Thomason JR, Gopalsamy A, Ciszewski G et al.. (2005) Inhibition of Tpl2 kinase and TNF-alpha production with 1,7-naphthyridine-3-carbonitriles: synthesis and structure-activity relationships.. Bioorg Med Chem Lett, 15 (23): (5288-92). [PMID:16165349] |
| 38. Sun L, Tran N, Liang C, Tang F, Rice A, Schreck R, Waltz K, Shawver LK, McMahon G, Tang C. (1999) Design, synthesis, and evaluations of substituted 3-[(3- or 4-carboxyethylpyrrol-2-yl)methylidenyl]indolin-2-ones as inhibitors of VEGF, FGF, and PDGF receptor tyrosine kinases.. J Med Chem, 42 (25): (5120-30). [PMID:10602697] |
| 39. Devadas B, Selness SR, Xing L, Madsen HM, Marrufo LD, Shieh H, Messing DM, Yang JZ, Morgan HM, Anderson GD et al.. (2011) Substituted N-aryl-6-pyrimidinones: a new class of potent, selective, and orally active p38 MAP kinase inhibitors.. Bioorg Med Chem Lett, 21 (13): (3856-60). [PMID:21620699] |
| 40. Zhou G, Zorn N, Ting P, Aslanian R, Lin M, Cook J, Lachowicz J, Lin A, Smith M, Hwa J et al.. (2014) Development of novel benzomorpholine class of diacylglycerol acyltransferase I inhibitors.. ACS Med Chem Lett, 5 (5): (544-9). [PMID:24900877] |
| 41. Aston NM, Bamborough P, Buckton JB, Edwards CD, Holmes DS, Jones KL, Patel VK, Smee PA, Somers DO, Vitulli G et al.. (2009) p38alpha mitogen-activated protein kinase inhibitors: optimization of a series of biphenylamides to give a molecule suitable for clinical progression.. J Med Chem, 52 (20): (6257-69). [PMID:19772287] |
| 42. Guagnano V, Furet P, Spanka C, Bordas V, Le Douget M, Stamm C, Brueggen J, Jensen MR, Schnell C, Schmid H et al.. (2011) Discovery of 3-(2,6-dichloro-3,5-dimethoxy-phenyl)-1-{6-[4-(4-ethyl-piperazin-1-yl)-phenylamino]-pyrimidin-4-yl}-1-methyl-urea (NVP-BGJ398), a potent and selective inhibitor of the fibroblast growth factor receptor family of receptor tyrosine kinase.. J Med Chem, 54 (20): (7066-83). [PMID:21936542] |
| 43. Rowbottom MW, Faraoni R, Chao Q, Campbell BT, Lai AG, Setti E, Ezawa M, Sprankle KG, Abraham S, Tran L et al.. (2012) Identification of 1-(3-(6,7-dimethoxyquinazolin-4-yloxy)phenyl)-3-(5-(1,1,1-trifluoro-2-methylpropan-2-yl)isoxazol-3-yl)urea hydrochloride (CEP-32496), a highly potent and orally efficacious inhibitor of V-RAF murine sarcoma viral oncogene homologue B1 (BRAF) V600E.. J Med Chem, 55 (3): (1082-105). [PMID:22168626] |
| 44. Nam HJ, Kim HP, Yoon YK, Hur HS, Song SH, Kim MS, Lee GS, Han SW, Im SA, Kim TY et al.. (2011) Antitumor activity of HM781-36B, an irreversible Pan-HER inhibitor, alone or in combination with cytotoxic chemotherapeutic agents in gastric cancer.. Cancer Lett, 302 (2): (155-65). [PMID:21306821] |
| 45. Cheng H, Li C, Bailey S, Baxi SM, Goulet L, Guo L, Hoffman J, Jiang Y, Johnson TO, Johnson TW et al.. (2013) Discovery of the Highly Potent PI3K/mTOR Dual Inhibitor PF-04979064 through Structure-Based Drug Design.. ACS Med Chem Lett, 4 (1): (91-7). [PMID:24900568] |
| 46. Fancelli D, Moll J, Varasi M, Bravo R, Artico R, Berta D, Bindi S, Cameron A, Candiani I, Cappella P et al.. (2006) 1,4,5,6-tetrahydropyrrolo[3,4-c]pyrazoles: identification of a potent Aurora kinase inhibitor with a favorable antitumor kinase inhibition profile.. J Med Chem, 49 (24): (7247-51). [PMID:17125279] |
| 47. Walter AO, Sjin RT, Haringsma HJ, Ohashi K, Sun J, Lee K, Dubrovskiy A, Labenski M, Zhu Z, Wang Z et al.. (2013) Discovery of a mutant-selective covalent inhibitor of EGFR that overcomes T790M-mediated resistance in NSCLC.. Cancer Discov, 3 (12): (1404-15). [PMID:24065731] |
| 48. Apsel B, Blair JA, Gonzalez B, Nazif TM, Feldman ME, Aizenstein B, Hoffman R, Williams RL, Shokat KM, Knight ZA. (2008) Targeted polypharmacology: discovery of dual inhibitors of tyrosine and phosphoinositide kinases.. Nat Chem Biol, 4 (11): (691-9). [PMID:18849971] |
| 49. Medina JR, Becker CJ, Blackledge CW, Duquenne C, Feng Y, Grant SW, Heerding D, Li WH, Miller WH, Romeril SP et al.. (2011) Structure-based design of potent and selective 3-phosphoinositide-dependent kinase-1 (PDK1) inhibitors.. J Med Chem, 54 (6): (1871-95). [PMID:21341675] |
| 50. Tam IY, Chung LP, Suen WS, Wang E, Wong MC, Ho KK, Lam WK, Chiu SW, Girard L, Minna JD et al.. (2006) Distinct epidermal growth factor receptor and KRAS mutation patterns in non-small cell lung cancer patients with different tobacco exposure and clinicopathologic features.. Clin Cancer Res, 12 (5): (1647-53). [PMID:16533793] |
| 51. Zarrinkar PP, Gunawardane RN, Cramer MD, Gardner MF, Brigham D, Belli B, Karaman MW, Pratz KW, Pallares G, Chao Q et al.. (2009) AC220 is a uniquely potent and selective inhibitor of FLT3 for the treatment of acute myeloid leukemia (AML).. Blood, 114 (14): (2984-92). [PMID:19654408] |
| 52. Changelian PS, Flanagan ME, Ball DJ, Kent CR, Magnuson KS, Martin WH, Rizzuti BJ, Sawyer PS, Perry BD, Brissette WH et al.. (2003) Prevention of organ allograft rejection by a specific Janus kinase 3 inhibitor.. Science, 302 (5646): (875-8). [PMID:14593182] |
| 53. Conway JG, McDonald B, Parham J, Keith B, Rusnak DW, Shaw E, Jansen M, Lin P, Payne A, Crosby RM et al.. (2005) Inhibition of colony-stimulating-factor-1 signaling in vivo with the orally bioavailable cFMS kinase inhibitor GW2580.. Proc Natl Acad Sci USA, 102 (44): (16078-83). [PMID:16249345] |
| 54. Misra RN, Xiao HY, Kim KS, Lu S, Han WC, Barbosa SA, Hunt JT, Rawlins DB, Shan W, Ahmed SZ et al.. (2004) N-(cycloalkylamino)acyl-2-aminothiazole inhibitors of cyclin-dependent kinase 2. N-[5-[[[5-(1,1-dimethylethyl)-2-oxazolyl]methyl]thio]-2-thiazolyl]-4- piperidinecarboxamide (BMS-387032), a highly efficacious and selective antitumor agent.. J Med Chem, 47 (7): (1719-28). [PMID:15027863] |
| 55. Li D, Ambrogio L, Shimamura T, Kubo S, Takahashi M, Chirieac LR, Padera RF, Shapiro GI, Baum A, Himmelsbach F et al.. (2008) BIBW2992, an irreversible EGFR/HER2 inhibitor highly effective in preclinical lung cancer models.. Oncogene, 27 (34): (4702-11). [PMID:18408761] |
| 56. Trudel S, Li ZH, Wei E, Wiesmann M, Chang H, Chen C, Reece D, Heise C, Stewart AK. (2005) CHIR-258, a novel, multitargeted tyrosine kinase inhibitor for the potential treatment of t(4;14) multiple myeloma.. Blood, 105 (7): (2941-8). [PMID:15598814] |
| 57. Carlomagno F, Vitagliano D, Guida T, Ciardiello F, Tortora G, Vecchio G, Ryan AJ, Fontanini G, Fusco A, Santoro M. (2002) ZD6474, an orally available inhibitor of KDR tyrosine kinase activity, efficiently blocks oncogenic RET kinases.. Cancer Res, 62 (24): (7284-90). [PMID:12499271] |
| 58. Goodfellow VS, Loweth CJ, Ravula SB, Wiemann T, Nguyen T, Xu Y, Todd DE, Sheppard D, Pollack S, Polesskaya O et al.. (2013) Discovery, synthesis, and characterization of an orally bioavailable, brain penetrant inhibitor of mixed lineage kinase 3.. J Med Chem, 56 (20): (8032-48). [PMID:24044867] |
| 59. Lee SL, Hsu EC, Chou CC, Chuang HC, Bai LY, Kulp SK, Chen CS. (2011) Identification and characterization of a novel integrin-linked kinase inhibitor.. J Med Chem, 54 (18): (6364-74). [PMID:21823616] |
| 60. Hall MD, Salam NK, Hellawell JL, Fales HM, Kensler CB, Ludwig JA, Szakács G, Hibbs DE, Gottesman MM. (2009) Synthesis, activity, and pharmacophore development for isatin-beta-thiosemicarbazones with selective activity toward multidrug-resistant cells.. J Med Chem, 52 (10): (3191-204). [PMID:19397322] |
| 61. Lafleur K, Huang D, Zhou T, Caflisch A, Nevado C. (2009) Structure-based optimization of potent and selective inhibitors of the tyrosine kinase erythropoietin producing human hepatocellular carcinoma receptor B4 (EphB4).. J Med Chem, 52 (20): (6433-46). [PMID:19788238] |
| 62. Li X, Zuo Y, Tang G, Wang Y, Zhou Y, Wang X, Guo T, Xia M, Ding N, Pan Z. (2014) Discovery of a series of 2,5-diaminopyrimidine covalent irreversible inhibitors of Bruton's tyrosine kinase with in vivo antitumor activity.. J Med Chem, 57 (12): (5112-28). [PMID:24915291] |
| 63. Pandey A, Volkots DL, Seroogy JM, Rose JW, Yu JC, Lambing JL, Hutchaleelaha A, Hollenbach SJ, Abe K, Giese NA et al.. (2002) Identification of orally active, potent, and selective 4-piperazinylquinazolines as antagonists of the platelet-derived growth factor receptor tyrosine kinase family.. J Med Chem, 45 (17): (3772-93). [PMID:12166950] |
| 64. Coombs TC, Tanega C, Shen M, Wang JL, Auld DS, Gerritz SW, Schoenen FJ, Thomas CJ, Aubé J. (2013) Small-molecule pyrimidine inhibitors of the cdc2-like (Clk) and dual specificity tyrosine phosphorylation-regulated (Dyrk) kinases: development of chemical probe ML315.. Bioorg Med Chem Lett, 23 (12): (3654-61). [PMID:23642479] |
| 65. Millan DS, Bunnage ME, Burrows JL, Butcher KJ, Dodd PG, Evans TJ, Fairman DA, Hughes SJ, Kilty IC, Lemaitre A et al.. (2011) Design and synthesis of inhaled p38 inhibitors for the treatment of chronic obstructive pulmonary disease.. J Med Chem, 54 (22): (7797-814). [PMID:21888439] |
| 66. Panek RL, Lu GH, Klutchko SR, Batley BL, Dahring TK, Hamby JM, Hallak H, Doherty AM, Keiser JA. (1997) In vitro pharmacological characterization of PD 166285, a new nanomolar potent and broadly active protein tyrosine kinase inhibitor.. J Pharmacol Exp Ther, 283 (3): (1433-44). [PMID:9400019] |
| 67. Hudkins RL, Becknell NC, Zulli AL, Underiner TL, Angeles TS, Aimone LD, Albom MS, Chang H, Miknyoczki SJ, Hunter K et al.. (2012) Synthesis and biological profile of the pan-vascular endothelial growth factor receptor/tyrosine kinase with immunoglobulin and epidermal growth factor-like homology domains 2 (VEGF-R/TIE-2) inhibitor 11-(2-methylpropyl)-12,13-dihydro-2-methyl-8-(pyrimidin-2-ylamino)-4H-indazolo[5,4-a]pyrrolo[3,4-c]carbazol-4-one (CEP-11981): a novel oncology therapeutic agent.. J Med Chem, 55 (2): (903-13). [PMID:22148921] |
| 68. Okuzumi T, Fiedler D, Zhang C, Gray DC, Aizenstein B, Hoffman R, Shokat KM. (2009) Inhibitor hijacking of Akt activation.. Nat Chem Biol, 5 (7): (484-93). [PMID:19465931] |
| 69. Ott GR, Tripathy R, Cheng M, McHugh R, Anzalone AV, Underiner TL, Curry MA, Quail MR, Lu L, Wan W et al.. (2010) Discovery of a potent inhibitor of anaplastic lymphoma kinase with in vivo antitumor activity.. ACS Med Chem Lett, 1 (9): (493-8). [PMID:24900237] |
| 70. Antczak C, Mahida JP, Bhinder B, Calder PA, Djaballah H. (2012) A high-content biosensor-based screen identifies cell-permeable activators and inhibitors of EGFR function: implications in drug discovery.. J Biomol Screen, 17 (7): (885-99). [PMID:22573732] |
| 71. Papeo G, Posteri H, Borghi D, Busel AA, Caprera F, Casale E, Ciomei M, Cirla A, Corti E, D'Anello M et al.. (2015) Discovery of 2-[1-(4,4-Difluorocyclohexyl)piperidin-4-yl]-6-fluoro-3-oxo-2,3-dihydro-1H-isoindole-4-carboxamide (NMS-P118): A Potent, Orally Available, and Highly Selective PARP-1 Inhibitor for Cancer Therapy.. J Med Chem, 58 (17): (6875-98). [PMID:26222319] |
| 72. Li B, Cociorva OM, Nomanbhoy T, Weissig H, Li Q, Nakamura K, Liyanage M, Zhang MC, Shih AY, Aban A et al.. (2013) Hit-to-lead optimization and kinase selectivity of imidazo[1,2-a]quinoxalin-4-amine derived JNK1 inhibitors.. Bioorg Med Chem Lett, 23 (18): (5217-22). [PMID:23916259] |
| 73. Cai X, Zhai HX, Wang J, Forrester J, Qu H, Yin L, Lai CJ, Bao R, Qian C. (2010) Discovery of 7-(4-(3-ethynylphenylamino)-7-methoxyquinazolin-6-yloxy)-N-hydroxyheptanamide (CUDc-101) as a potent multi-acting HDAC, EGFR, and HER2 inhibitor for the treatment of cancer.. J Med Chem, 53 (5): (2000-9). [PMID:20143778] |
| 74. Byrd JC, Harrington B, O'Brien S, Jones JA, Schuh A, Devereux S, Chaves J, Wierda WG, Awan FT, Brown JR et al.. (2016) Acalabrutinib (ACP-196) in Relapsed Chronic Lymphocytic Leukemia.. N Engl J Med, 374 (4): (323-32). [PMID:26641137] |
| 75. Tang Z, Yuan X, Du R, Cheung SH, Zhang G, Wei J, Zhao Y, Feng Y, Peng H, Zhang Y et al.. (2015) BGB-283, a Novel RAF Kinase and EGFR Inhibitor, Displays Potent Antitumor Activity in BRAF-Mutated Colorectal Cancers.. Mol Cancer Ther, 14 (10): (2187-97). [PMID:26208524] |
| 76. Buchholz S, Schally AV, Engel JB, Hohla F, Heinrich E, Koester F, Varga JL, Halmos G. (2007) Potentiation of mammary cancer inhibition by combination of antagonists of growth hormone-releasing hormone with docetaxel.. Proc Natl Acad Sci USA, 104 (6): (1943-6). [PMID:17261802] |
| 77. Wang S, Cang S, Liu D. (2016) Third-generation inhibitors targeting EGFR T790M mutation in advanced non-small cell lung cancer.. J Hematol Oncol, 9 (34). [PMID:27071706] |
| 78. Derrien A, Druey KM. (2001) RGS16 function is regulated by epidermal growth factor receptor-mediated tyrosine phosphorylation.. J Biol Chem, 276 (51): (48532-8). [PMID:11602604] |
| 79. Jia Y, Yun CH, Park E, Ercan D, Manuia M, Juarez J, Xu C, Rhee K, Chen T, Zhang H et al.. (2016) Overcoming EGFR(T790M) and EGFR(C797S) resistance with mutant-selective allosteric inhibitors.. Nature, 534 (7605): (129-32). [PMID:27251290] |
| 80. Aronov AM, Tang Q, Martinez-Botella G, Bemis GW, Cao J, Chen G, Ewing NP, Ford PJ, Germann UA, Green J et al.. (2009) Structure-guided design of potent and selective pyrimidylpyrrole inhibitors of extracellular signal-regulated kinase (ERK) using conformational control.. J Med Chem, 52 (20): (6362-8). [PMID:19827834] |
| 81. Kim KH, Maderna A, Schnute ME, Hegen M, Mohan S, Miyashiro J, Lin L, Li E, Keegan S, Lussier J et al.. (2011) Imidazo[1,5-a]quinoxalines as irreversible BTK inhibitors for the treatment of rheumatoid arthritis.. Bioorg Med Chem Lett, 21 (21): (6258-63). [PMID:21958547] |
| 82. Phillips RM. (2016) Targeting the hypoxic fraction of tumours using hypoxia-activated prodrugs.. Cancer Chemother Pharmacol, 77 (3): (441-57). [PMID:26811177] |
| 83. Hobson AD, Harris CM, van der Kam EL, Turner SC, Abibi A, Aguirre AL, Bousquet P, Kebede T, Konopacki DB, Gintant G et al.. (2015) Discovery of A-971432, An Orally Bioavailable Selective Sphingosine-1-Phosphate Receptor 5 (S1P5) Agonist for the Potential Treatment of Neurodegenerative Disorders.. J Med Chem, 58 (23): (9154-70). [PMID:26509640] |
| 84. Telliez JB, Dowty ME, Wang L, Jussif J, Lin T, Li L, Moy E, Balbo P, Li W, Zhao Y et al.. (2016) Discovery of a JAK3-Selective Inhibitor: Functional Differentiation of JAK3-Selective Inhibition over pan-JAK or JAK1-Selective Inhibition.. ACS Chem Biol, 11 (12): (3442-3451). [PMID:27791347] |
| 85. Li X, Yang C, Wan H, Zhang G, Feng J, Zhang L, Chen X, Zhong D, Lou L, Tao W et al.. (2017) Discovery and development of pyrotinib: A novel irreversible EGFR/HER2 dual tyrosine kinase inhibitor with favorable safety profiles for the treatment of breast cancer.. Eur J Pharm Sci, 110 (51-61). [PMID:28115222] |
| 86. Tan L, Gurbani D, Weisberg EL, Jones DS, Rao S, Singer WD, Bernard FM, Mowafy S, Jenney A, Du G et al.. (2017) Studies of TAK1-centered polypharmacology with novel covalent TAK1 inhibitors.. Bioorg Med Chem, 25 (4): (1320-1328). [PMID:28038940] |
| 87. Burger MT, Nishiguchi G, Han W, Lan J, Simmons R, Atallah G, Ding Y, Tamez V, Zhang Y, Mathur M et al.. (2015) Identification of N-(4-((1R,3S,5S)-3-Amino-5-methylcyclohexyl)pyridin-3-yl)-6-(2,6-difluorophenyl)-5-fluoropicolinamide (PIM447), a Potent and Selective Proviral Insertion Site of Moloney Murine Leukemia (PIM) 1, 2, and 3 Kinase Inhibitor in Clinical Trials for Hematological Malignancies.. J Med Chem, 58 (21): (8373-86). [PMID:26505898] |
| 88. Xie H, Lin L, Tong L, Jiang Y, Zheng M, Chen Z, Jiang X, Zhang X, Ren X, Qu W et al.. (2011) AST1306, a novel irreversible inhibitor of the epidermal growth factor receptor 1 and 2, exhibits antitumor activity both in vitro and in vivo.. PLoS ONE, 6 (7): (e21487). [PMID:21789172] |
| 89. Patel S, Harris SF, Gibbons P, Deshmukh G, Gustafson A, Kellar T, Lin H, Liu X, Liu Y, Liu Y et al.. (2015) Scaffold-Hopping and Structure-Based Discovery of Potent, Selective, And Brain Penetrant N-(1H-Pyrazol-3-yl)pyridin-2-amine Inhibitors of Dual Leucine Zipper Kinase (DLK, MAP3K12).. J Med Chem, 58 (20): (8182-99). [PMID:26431428] |
| 90. Das J, Furch JA, Liu C, Moquin RV, Lin J, Spergel SH, McIntyre KW, Shuster DJ, O'Day KD, Penhallow B et al.. (2006) Discovery and SAR of 2-amino-5-(thioaryl)thiazoles as potent and selective Itk inhibitors.. Bioorg Med Chem Lett, 16 (14): (3706-12). [PMID:16682193] |
| 91. Jarantow SW, Bushey BS, Pardinas JR, Boakye K, Lacy ER, Sanders R, Sepulveda MA, Moores SL, Chiu ML. (2015) Impact of Cell-surface Antigen Expression on Target Engagement and Function of an Epidermal Growth Factor Receptor × c-MET Bispecific Antibody.. J Biol Chem, 290 (41): (24689-704). [PMID:26260789] |
| 92. Qing-Shan Li,Xian-Hai Lv,Yan-Bin Zhang,Jing-Jun Dong,Wen-Ping Zhou,Yang Yang,Hai-Liang Zhu. (2012-10-03) Identification of novel 3,5-diarylpyrazoline derivatives containing salicylamide moiety as potential anti-melanoma agents.. Bioorganic & medicinal chemistry letters, 22 ((21)): (6596-6601). [PMID:23025996] |
| 93. Seunghee Hong,Jinhee Kim,Sun-Mi Yun,Hyunseung Lee,Yoonsu Park,Soon-Sun Hong,Sungwoo Hong. (2013-04-23) Discovery of new benzothiazole-based inhibitors of breakpoint cluster region-Abelson kinase including the T315I mutant.. Journal of medicinal chemistry, 56 ((9)): (3531-3545). [PMID:23600806] |
| 94. Weihe Zhang,Dehui Zhang,Michael A Stashko,Deborah DeRyckere,Debra Hunter,Dmitri Kireev,Michael J Miley,Christopher Cummings,Minjung Lee,Jacqueline Norris-Drouin,Wendy M Stewart,Susan Sather,Yingqiu Zhou,Gregory Kirkpatrick,Mischa Machius,William P Janzen,H Shelton Earp,Douglas K Graham,Stephen V Frye,Xiaodong Wang. (2013-11-08) Pseudo-cyclization through intramolecular hydrogen bond enables discovery of pyridine substituted pyrimidines as new Mer kinase inhibitors.. Journal of medicinal chemistry, 56 ((23)): (9683-9692). [PMID:24195762] |
| 95. Ajit Dhananjay Jagtap,Pei-Teh Chang,Jia-Rong Liu,Hsiao-Chun Wang,Nagendra B Kondekar,Li-Jiuan Shen,Hsiang-Wen Tseng,Grace Shiahuy Chen,Ji-Wang Chern. (2014-08-05) Novel acylureidoindolin-2-one derivatives as dual Aurora B/FLT3 inhibitors for the treatment of acute myeloid leukemia.. European journal of medicinal chemistry, 85 (268-288). [PMID:25089810] |
| 96. Emily J Hanan,Charles Eigenbrot,Marian C Bryan,Daniel J Burdick,Bryan K Chan,Yuan Chen,Jennafer Dotson,Robert A Heald,Philip S Jackson,Hank La,Michael D Lainchbury,Shiva Malek,Hans E Purkey,Gabriele Schaefer,Stephen Schmidt,Eileen M Seward,Steve Sideris,Christine Tam,Shumei Wang,Siew Kuen Yeap,Ivana Yen,Jianping Yin,Christine Yu,Inna Zilberleyb,Timothy P Heffron. (2014-11-11) Discovery of selective and noncovalent diaminopyrimidine-based inhibitors of epidermal growth factor receptor containing the T790M resistance mutation.. Journal of medicinal chemistry, 57 ((23)): (10176-10191). [PMID:25383627] |
| 97. Sharon Gauci,Andreas O Helbig,Monique Slijper,Jeroen Krijgsveld,Albert J R Heck,Shabaz Mohammed. (2009-05-06) Lys-N and trypsin cover complementary parts of the phosphoproteome in a refined SCX-based approach.. Analytical chemistry, 81 ((11)): (4493-4501). [PMID:19413330] |
| 98. Xiaoqing Wu,Mingdong Li,Yang Qu,Wenhua Tang,Youguang Zheng,Jiqin Lian,Min Ji,Liang Xu. (2010-05-15) Design and synthesis of novel Gefitinib analogues with improved anti-tumor activity.. Bioorganic & medicinal chemistry, 18 ((11)): (3812-3822). [PMID:20466555] |
| 99. Bing Yu,Li-da Tang,Yi-Liang Li,Shu-Hui Song,Xiao-Liang Ji,Mu-Sen Lin,Chun-Fu Wu. (2011-12-16) Design, synthesis and antitumor activity of 4-aminoquinazoline derivatives targeting VEGFR-2 tyrosine kinase.. Bioorganic & medicinal chemistry letters, 22 ((1)): (110-114). [PMID:22169262] |
| 100. Xiao-Guang Bai,Dong-Ke Yu,Ju-Xian Wang,Hao Zhang,Hong-Wei He,Rong-Guang Shao,Xue-Mei Li,Yu-Cheng Wang. (2012-10-06) Design, synthesis and anticancer activity of 1-acyl-3-amino-1,4,5,6-tetrahydropyrrolo[3,4-c]pyrazole derivatives.. Bioorganic & medicinal chemistry letters, 22 ((22)): (6947-6951). [PMID:23036956] |
| 101. Revesz L, Blum E, Di Padova FE, Buhl T, Feifel R, Gram H, Hiestand P, Manning U, Rucklin G.. (2004) Novel p38 inhibitors with potent oral efficacy in several models of rheumatoid arthritis.. Bioorg Med Chem Lett, 14 (13): (3595-3599). [PMID:15177482] [10.1016/j.bmcl.2004.03.106] |
| 102. Revesz L, Blum E, Di Padova FE, Buhl T, Feifel R, Gram H, Hiestand P, Manning U, Rucklin G.. (2004) SAR of benzoylpyridines and benzophenones as p38alpha MAP kinase inhibitors with oral activity.. Bioorg Med Chem Lett, 14 (13): (3601-3605). [PMID:15177483] [10.1016/j.bmcl.2004.03.111] |
| 103. Liverton NJ, Butcher JW, Claiborne CF, Claremon DA, Libby BE, Nguyen KT, Pitzenberger SM, Selnick HG, Smith GR, Tebben A, Vacca JP, Varga SL, Agarwal L, Dancheck K, Forsyth AJ, Fletcher DS, Frantz B, Hanlon WA, Harper CF, Hofsess SJ, Kostura M, Lin J, Luell S, O'Neill EA, O'Keefe SJ.. (1999) Design and synthesis of potent, selective, and orally bioavailable tetrasubstituted imidazole inhibitors of p38 mitogen-activated protein kinase.. J Med Chem, 42 (12): (2180-2190). [PMID:10377223] [10.1021/jm9805236] |
| 104. Berger M, Albrecht B, Berces A, Ettmayer P, Neruda W, Woisetschläger M.. (2001) S(+)-4-(1-Phenylethylamino)quinazolines as inhibitors of human immunoglobulin E synthesis: potency is dictated by stereochemistry and atomic point charges at N-1.. J Med Chem, 44 (18): (3031-3038). [PMID:11520212] [10.1021/jm010888h] |
| 105. Pevarello P, Brasca MG, Amici R, Orsini P, Traquandi G, Corti L, Piutti C, Sansonna P, Villa M, Pierce BS, Pulici M, Giordano P, Martina K, Fritzen EL, Nugent RA, Casale E, Cameron A, Ciomei M, Roletto F, Isacchi A, Fogliatto G, Pesenti E, Pastori W, Marsiglio A, Leach KL, Clare PM, Fiorentini F, Varasi M, Vulpetti A, Warpehoski MA.. (2004) 3-Aminopyrazole inhibitors of CDK2/cyclin A as antitumor agents. 1. Lead finding.. J Med Chem, 47 (13): (3367-3380). [PMID:15189033] [10.1021/jm031145u] |
| 106. Borzilleri RM, Zheng X, Qian L, Ellis C, Cai ZW, Wautlet BS, Mortillo S, Jeyaseelan R, Kukral DW, Fura A, Kamath A, Vyas V, Tokarski JS, Barrish JC, Hunt JT, Lombardo LJ, Fargnoli J, Bhide RS.. (2005) Design, synthesis, and evaluation of orally active 4-(2,4-difluoro-5-(methoxycarbamoyl)phenylamino)pyrrolo[2,1-f][1,2,4]triazines as dual vascular endothelial growth factor receptor-2 and fibroblast growth factor receptor-1 inhibitors.. J Med Chem, 48 (12): (3991-4008). [PMID:15943473] [10.1021/jm0501275] |
| 107. Kuo GH, Prouty C, Wang A, Emanuel S, Deangelis A, Zhang Y, Song F, Beall L, Connolly PJ, Karnachi P, Chen X, Gruninger RH, Sechler J, Fuentes-Pesquera A, Middleton SA, Jolliffe L, Murray WV.. (2005) Synthesis and structure-activity relationships of pyrazine-pyridine biheteroaryls as novel, potent, and selective vascular endothelial growth factor receptor-2 inhibitors.. J Med Chem, 48 (15): (4892-4909). [PMID:16033269] [10.1021/jm058205b] |
| 108. Kuo GH, Wang A, Emanuel S, Deangelis A, Zhang R, Connolly PJ, Murray WV, Gruninger RH, Sechler J, Fuentes-Pesquera A, Johnson D, Middleton SA, Jolliffe L, Chen X.. (2005) Synthesis and discovery of pyrazine-pyridine biheteroaryl as a novel series of potent vascular endothelial growth factor receptor-2 inhibitors.. J Med Chem, 48 (6): (1886-1900). [PMID:15771433] [10.1021/jm040099a] |
| 109. Revesz L, Blum E, Di Padova FE, Buhl T, Feifel R, Gram H, Hiestand P, Manning U, Neumann U, Rucklin G.. (2006) Pyrazoloheteroaryls: novel p38alpha MAP kinase inhibiting scaffolds with oral activity.. Bioorg Med Chem Lett, 16 (2): (262-266). [PMID:16249085] [10.1016/j.bmcl.2005.10.015] |
| 110. McDermott LA, Higgins B, Simcox M, Luk KC, Nevins T, Kolinsky K, Smith M, Yang H, Li JK, Chen Y, Ke J, Mallalieu N, Egan T, Kolis S, Railkar A, Gerber L, Liu JJ, Konzelmann F, Zhang Z, Flynn T, Morales O, Chen Y.. (2006) Biological evaluation of a multi-targeted small molecule inhibitor of tumor-induced angiogenesis.. Bioorg Med Chem Lett, 16 (7): (1950-1953). [PMID:16460940] [10.1016/j.bmcl.2005.12.092] |
| 111. Zhao H, Serby MD, Xin Z, Szczepankiewicz BG, Liu M, Kosogof C, Liu B, Nelson LT, Johnson EF, Wang S, Pederson T, Gum RJ, Clampit JE, Haasch DL, Abad-Zapatero C, Fry EH, Rondinone C, Trevillyan JM, Sham HL, Liu G.. (2006) Discovery of potent, highly selective, and orally bioavailable pyridine carboxamide c-Jun NH2-terminal kinase inhibitors.. J Med Chem, 49 (15): (4455-4458). [PMID:16854050] [10.1021/jm060465l] |
| 112. Borzilleri RM, Bhide RS, Barrish JC, D'Arienzo CJ, Derbin GM, Fargnoli J, Hunt JT, Jeyaseelan R, Kamath A, Kukral DW, Marathe P, Mortillo S, Qian L, Tokarski JS, Wautlet BS, Zheng X, Lombardo LJ.. (2006) Discovery and evaluation of N-cyclopropyl- 2,4-difluoro-5-((2-(pyridin-2-ylamino)thiazol-5- ylmethyl)amino)benzamide (BMS-605541), a selective and orally efficacious inhibitor of vascular endothelial growth factor receptor-2.. J Med Chem, 49 (13): (3766-3769). [PMID:16789733] [10.1021/jm060347y] |
| 113. Hu Y, Green N, Gavrin LK, Janz K, Kaila N, Li HQ, Thomason JR, Cuozzo JW, Hall JP, Hsu S, Nickerson-Nutter C, Telliez JB, Lin LL, Tam S.. (2006) Inhibition of Tpl2 kinase and TNFalpha production with quinoline-3-carbonitriles for the treatment of rheumatoid arthritis.. Bioorg Med Chem Lett, 16 (23): (6067-6072). [PMID:16973359] [10.1016/j.bmcl.2006.08.102] |
| 114. Mukaiyama H, Nishimura T, Kobayashi S, Ozawa T, Kamada N, Komatsu Y, Kikuchi S, Oonota H, Kusama H.. (2007) Synthesis and c-Src inhibitory activity of imidazo[1,5-a]pyrazine derivatives as an agent for treatment of acute ischemic stroke.. Bioorg Med Chem, 15 (2): (868-885). [PMID:17095233] [10.1016/j.bmc.2006.10.041] |
| 115. Potashman MH, Bready J, Coxon A, DeMelfi TM, DiPietro L, Doerr N, Elbaum D, Estrada J, Gallant P, Germain J, Gu Y, Harmange JC, Kaufman SA, Kendall R, Kim JL, Kumar GN, Long AM, Neervannan S, Patel VF, Polverino A, Rose P, Plas Sv, Whittington D, Zanon R, Zhao H.. (2007) Design, synthesis, and evaluation of orally active benzimidazoles and benzoxazoles as vascular endothelial growth factor-2 receptor tyrosine kinase inhibitors.. J Med Chem, 50 (18): (4351-4373). [PMID:17696416] [10.1021/jm070034i] |
| 116. Green N, Hu Y, Janz K, Li HQ, Kaila N, Guler S, Thomason J, Joseph-McCarthy D, Tam SY, Hotchandani R, Wu J, Huang A, Wang Q, Leung L, Pelker J, Marusic S, Hsu S, Telliez JB, Hall JP, Cuozzo JW, Lin LL.. (2007) Inhibitors of tumor progression loci-2 (Tpl2) kinase and tumor necrosis factor alpha (TNF-alpha) production: selectivity and in vivo antiinflammatory activity of novel 8-substituted-4-anilino-6-aminoquinoline-3-carbonitriles.. J Med Chem, 50 (19): (4728-4745). [PMID:17715908] [10.1021/jm070436q] |
| 117. Manetti F, Santucci A, Locatelli GA, Maga G, Spreafico A, Serchi T, Orlandini M, Bernardini G, Caradonna NP, Spallarossa A, Brullo C, Schenone S, Bruno O, Ranise A, Bondavalli F, Hoffmann O, Bologna M, Angelucci A, Botta M.. (2007) Identification of a novel pyrazolo[3,4-d]pyrimidine able to inhibit cell proliferation of a human osteogenic sarcoma in vitro and in a xenograft model in mice.. J Med Chem, 50 (23): (5579-5588). [PMID:17929792] [10.1021/jm061449r] |
| 118. Jang SW, Okada M, Sayeed I, Xiao G, Stein D, Jin P, Ye K.. (2007) Gambogic amide, a selective agonist for TrkA receptor that possesses robust neurotrophic activity, prevents neuronal cell death.. Proc Natl Acad Sci U S A, 104 (41): (16329-16334). [PMID:17911251] [10.1073/pnas.0706662104] |
| 119. McDermott U, Sharma SV, Dowell L, Greninger P, Montagut C, Lamb J, Archibald H, Raudales R, Tam A, Lee D, Rothenberg SM, Supko JG, Sordella R, Ulkus LE, Iafrate AJ, Maheswaran S, Njauw CN, Tsao H, Drew L, Hanke JH, Ma XJ, Erlander MG, Gray NS, Haber DA, Settleman J.. (2007) Identification of genotype-correlated sensitivity to selective kinase inhibitors by using high-throughput tumor cell line profiling.. Proc Natl Acad Sci U S A, 104 (50): (19936-19941). [PMID:18077425] [10.1073/pnas.0707498104] |
| 120. Rellos P, Ivins FJ, Baxter JE, Pike A, Nott TJ, Parkinson DM, Das S, Howell S, Fedorov O, Shen QY, Fry AM, Knapp S, Smerdon SJ.. (2007) Structure and regulation of the human Nek2 centrosomal kinase.. J Biol Chem, 282 (9): (6833-6842). [PMID:17197699] [10.1074/jbc.m609721200] |
| 121. Slack-Davis JK, Martin KH, Tilghman RW, Iwanicki M, Ung EJ, Autry C, Luzzio MJ, Cooper B, Kath JC, Roberts WG, Parsons JT.. (2007) Cellular characterization of a novel focal adhesion kinase inhibitor.. J Biol Chem, 282 (20): (14845-14852). [PMID:17395594] [10.1074/jbc.m606695200] |
| 122. Grice CA, Tays KL, Savall BM, Wei J, Butler CR, Axe FU, Bembenek SD, Fourie AM, Dunford PJ, Lundeen K, Coles F, Xue X, Riley JP, Williams KN, Karlsson L, Edwards JP.. (2008) Identification of a potent, selective, and orally active leukotriene a4 hydrolase inhibitor with anti-inflammatory activity.. J Med Chem, 51 (14): (4150-4169). [PMID:18588282] [10.1021/jm701575k] |
| 123. Feng Y, Yin Y, Weiser A, Griffin E, Cameron MD, Lin L, Ruiz C, Schürer SC, Inoue T, Rao PV, Schröter T, Lograsso P.. (2008) Discovery of substituted 4-(pyrazol-4-yl)-phenylbenzodioxane-2-carboxamides as potent and highly selective Rho kinase (ROCK-II) inhibitors.. J Med Chem, 51 (21): (6642-6645). [PMID:18834107] [10.1021/jm800986w] |
| 124. Hirabayashi A, Mukaiyama H, Kobayashi H, Shiohara H, Nakayama S, Ozawa M, Miyazawa K, Misawa K, Ohnota H, Isaji M.. (2009) Structure-activity relationship studies of 5-benzylaminoimidazo[1,2-c]pyrimidine-8-carboxamide derivatives as potent, highly selective ZAP-70 kinase inhibitors.. Bioorg Med Chem, 17 (1): (284-294). [PMID:19010686] [10.1016/j.bmc.2008.10.070] |
| 125. Xia Z, Knaak C, Ma J, Beharry ZM, McInnes C, Wang W, Kraft AS, Smith CD.. (2009) Synthesis and evaluation of novel inhibitors of Pim-1 and Pim-2 protein kinases.. J Med Chem, 52 (1): (74-86). [PMID:19072652] [10.1021/jm800937p] |
| 126. D'Angelo ND, Bellon SF, Booker SK, Cheng Y, Coxon A, Dominguez C, Fellows I, Hoffman D, Hungate R, Kaplan-Lefko P, Lee MR, Li C, Liu L, Rainbeau E, Reider PJ, Rex K, Siegmund A, Sun Y, Tasker AS, Xi N, Xu S, Yang Y, Zhang Y, Burgess TL, Dussault I, Kim TS.. (2008) Design, synthesis, and biological evaluation of potent c-Met inhibitors.. J Med Chem, 51 (18): (5766-5779). [PMID:18763753] [10.1021/jm8006189] |
| 127. Cole DC, Asselin M, Brennan A, Czerwinski R, Ellingboe JW, Fitz L, Greco R, Huang X, Joseph-McCarthy D, Kelly MF, Kirisits M, Lee J, Li Y, Morgan P, Stock JR, Tsao DH, Wissner A, Yang X, Chaudhary D.. (2008) Identification, characterization and initial hit-to-lead optimization of a series of 4-arylamino-3-pyridinecarbonitrile as protein kinase C theta (PKCtheta) inhibitors.. J Med Chem, 51 (19): (5958-5963). [PMID:18783200] [10.1021/jm800214a] |
| 128. Golubovskaya VM, Nyberg C, Zheng M, Kweh F, Magis A, Ostrov D, Cance WG.. (2008) A small molecule inhibitor, 1,2,4,5-benzenetetraamine tetrahydrochloride, targeting the y397 site of focal adhesion kinase decreases tumor growth.. J Med Chem, 51 (23): (7405-7416). [PMID:18989950] [10.1021/jm800483v] |
| 129. Peach ML, Tan N, Choyke SJ, Giubellino A, Athauda G, Burke TR, Nicklaus MC, Bottaro DP.. (2009) Directed discovery of agents targeting the Met tyrosine kinase domain by virtual screening.. J Med Chem, 52 (4): (943-951). [PMID:19199650] [10.1021/jm800791f] |
| 130. Hubbard RD, Bamaung NY, Fidanze SD, Erickson SA, Palazzo F, Wilsbacher JL, Zhang Q, Tucker LA, Hu X, Kovar P, Osterling DJ, Johnson EF, Bouska J, Wang J, Davidsen SK, Bell RL, Sheppard GS.. (2009) Development of multitargeted inhibitors of both the insulin-like growth factor receptor (IGF-IR) and members of the epidermal growth factor family of receptor tyrosine kinases.. Bioorg Med Chem Lett, 19 (6): (1718-1721). [PMID:19217287] [10.1016/j.bmcl.2009.01.086] |
| 131. Lee K, Kim J, Jeong KW, Lee KW, Lee Y, Song JY, Kim MS, Lee GS, Kim Y.. (2009) Structure-based virtual screening of Src kinase inhibitors.. Bioorg Med Chem, 17 (8): (3152-3161). [PMID:19321350] [10.1016/j.bmc.2009.02.054] |
| 132. Hur W, Velentza A, Kim S, Flatauer L, Jiang X, Valente D, Mason DE, Suzuki M, Larson B, Zhang J, Zagorska A, Didonato M, Nagle A, Warmuth M, Balk SP, Peters EC, Gray NS.. (2008) Clinical stage EGFR inhibitors irreversibly alkylate Bmx kinase.. Bioorg Med Chem Lett, 18 (22): (5916-5919). [PMID:18667312] [10.1016/j.bmcl.2008.07.062] |
| 133. Sunami S, Nishimura T, Nishimura I, Ito S, Arakawa H, Ohkubo M.. (2009) Synthesis and biological activities of topoisomerase I inhibitors, 6-arylmethylamino analogues of edotecarin.. J Med Chem, 52 (10): (3225-3237). [PMID:19397324] [10.1021/jm801641t] |
| 134. Lumeras W, Caturla F, Vidal L, Esteve C, Balagué C, Orellana A, Domínguez M, Roca R, Huerta JM, Godessart N, Vidal B.. (2009) Design, synthesis, and structure-activity relationships of aminopyridine N-oxides, a novel scaffold for the potent and selective inhibition of p38 mitogen activated protein kinase.. J Med Chem, 52 (17): (5531-5545). [PMID:19678708] [10.1021/jm9008604] |
| 135. Li R, Pourpak A, Morris SW.. (2009) Inhibition of the insulin-like growth factor-1 receptor (IGF1R) tyrosine kinase as a novel cancer therapy approach.. J Med Chem, 52 (16): (4981-5004). [PMID:19610618] [10.1021/jm9002395] |
| 136. Park BS, El-Deeb IM, Yoo KH, Oh CH, Cho SJ, Han DK, Lee HS, Lee JY, Lee SH.. (2009) Design, synthesis and biological evaluation of new potent and highly selective ROS1-tyrosine kinase inhibitor.. Bioorg Med Chem Lett, 19 (16): (4720-4723). [PMID:19596575] [10.1016/j.bmcl.2009.06.066] |
| 137. Zuliani V, Carmi C, Rivara M, Fantini M, Lodola A, Vacondio F, Bordi F, Plazzi PV, Cavazzoni A, Galetti M, Alfieri RR, Petronini PG, Mor M.. (2009) 5-Benzylidene-hydantoins: synthesis and antiproliferative activity on A549 lung cancer cell line.. Eur J Med Chem, 44 (9): (3471-3479). [PMID:19268405] [10.1016/j.ejmech.2009.01.035] |
| 138. Cha MY, Lee KO, Kim JW, Lee CG, Song JY, Kim YH, Lee GS, Park SB, Kim MS.. (2009) Discovery of a novel Her-1/Her-2 dual tyrosine kinase inhibitor for the treatment of Her-1 selective inhibitor-resistant non-small cell lung cancer.. J Med Chem, 52 (21): (6880-6888). [PMID:19888761] [10.1021/jm901146p] |
| 139. Li J, Kaoud TS, Laroche C, Dalby KN, Kerwin SM.. (2009) Synthesis and biological evaluation of p38alpha kinase-targeting dialkynylimidazoles.. Bioorg Med Chem Lett, 19 (22): (6293-6297). [PMID:19822424] [10.1016/j.bmcl.2009.09.094] |
| 140. Shomin CD, Meyer SC, Ghosh I.. (2009) Staurosporine tethered peptide ligands that target cAMP-dependent protein kinase (PKA): optimization and selectivity profiling.. Bioorg Med Chem, 17 (17): (6196-6202). [PMID:19674907] [10.1016/j.bmc.2009.07.056] |
| 141. Gangjee A, Li W, Lin L, Zeng Y, Ihnat M, Warnke LA, Green DW, Cody V, Pace J, Queener SF.. (2009) Design, synthesis, and X-ray crystal structures of 2,4-diaminofuro[2,3-d]pyrimidines as multireceptor tyrosine kinase and dihydrofolate reductase inhibitors.. Bioorg Med Chem, 17 (20): (7324-7336). [PMID:19748785] [10.1016/j.bmc.2009.08.044] |
| 142. Wee XK, Yeo WK, Zhang B, Tan VB, Lim KM, Tay TE, Go ML.. (2009) Synthesis and evaluation of functionalized isoindigos as antiproliferative agents.. Bioorg Med Chem, 17 (21): (7562-7571). [PMID:19783149] [10.1016/j.bmc.2009.09.008] |
| 143. Ravindranathan KP, Mandiyan V, Ekkati AR, Bae JH, Schlessinger J, Jorgensen WL.. (2010) Discovery of novel fibroblast growth factor receptor 1 kinase inhibitors by structure-based virtual screening.. J Med Chem, 53 (4): (1662-1672). [PMID:20121196] [10.1021/jm901386e] |
| 144. Larroque-Lombard AL, Todorova M, Golabi N, Williams C, Jean-Claude BJ.. (2010) Synthesis and uptake of fluorescence-labeled Combi-molecules by P-glycoprotein-proficient and -deficient uterine sarcoma cells MES-SA and MES-SA/DX5.. J Med Chem, 53 (5): (2104-2113). [PMID:20151639] [10.1021/jm9016043] |
| 145. Qiao L, Choi S, Case A, Gainer TG, Seyb K, Glicksman MA, Lo DC, Stein RL, Cuny GD.. (2009) Structure-activity relationship study of EphB3 receptor tyrosine kinase inhibitors.. Bioorg Med Chem Lett, 19 (21): (6122-6126). [PMID:19783434] [10.1016/j.bmcl.2009.09.010] |
| 146. Felts AS, Saleh SA, Le U, Rodriguez AL, Weaver CD, Conn PJ, Lindsley CW, Emmitte KA.. (2009) Discovery and SAR of 6-substituted-4-anilinoquinazolines as non-competitive antagonists of mGlu5.. Bioorg Med Chem Lett, 19 (23): (6623-6626). [PMID:19854049] [10.1016/j.bmcl.2009.10.024] |
| 147. Lesuisse D, Dutruc-Rosset G, Tiraboschi G, Dreyer MK, Maignan S, Chevalier A, Halley F, Bertrand P, Burgevin MC, Quarteronet D, Rooney T.. (2010) Rational design of potent GSK3beta inhibitors with selectivity for Cdk1 and Cdk2.. Bioorg Med Chem Lett, 20 (6): (1985-1989). [PMID:20167481] [10.1016/j.bmcl.2010.01.114] |
| 148. Gangjee A, Namjoshi OA, Ihnat MA, Buchanan A.. (2010) The contribution of a 2-amino group on receptor tyrosine kinase inhibition and antiangiogenic activity in 4-anilinosubstituted pyrrolo[2,3-d]pyrimidines.. Bioorg Med Chem Lett, 20 (10): (3177-3181). [PMID:20403693] [10.1016/j.bmcl.2010.03.064] |
| 149. Deng X, Lim SM, Zhang J, Gray NS.. (2010) Broad spectrum alkynyl inhibitors of T315I Bcr-Abl.. Bioorg Med Chem Lett, 20 (14): (4196-4200). [PMID:20541934] [10.1016/j.bmcl.2010.05.043] |
| 150. Pisaneschi F, Nguyen QD, Shamsaei E, Glaser M, Robins E, Kaliszczak M, Smith G, Spivey AC, Aboagye EO.. (2010) Development of a new epidermal growth factor receptor positron emission tomography imaging agent based on the 3-cyanoquinoline core: synthesis and biological evaluation.. Bioorg Med Chem, 18 (18): (6634-6645). [PMID:20797871] [10.1016/j.bmc.2010.08.004] |
| 151. Mahboobi S, Sellmer A, Winkler M, Eichhorn E, Pongratz H, Ciossek T, Baer T, Maier T, Beckers T.. (2010) Novel chimeric histone deacetylase inhibitors: a series of lapatinib hybrides as potent inhibitors of epidermal growth factor receptor (EGFR), human epidermal growth factor receptor 2 (HER2), and histone deacetylase activity.. J Med Chem, 53 (24): (8546-8555). [PMID:21080629] [10.1021/jm100665z] |
| 152. Ye P, Kuhn C, Juan M, Sharma R, Connolly B, Alton G, Liu H, Stanton R, Kablaoui NM.. (2011) Potent and selective thiophene urea-templated inhibitors of S6K.. Bioorg Med Chem Lett, 21 (2): (849-852). [PMID:21185721] [10.1016/j.bmcl.2010.11.069] |
| 153. Probst GD, Bowers S, Sealy JM, Truong AP, Hom RK, Galemmo RA, Konradi AW, Sham HL, Quincy DA, Pan H, Yao N, Lin M, Tóth G, Artis DR, Zmolek W, Wong K, Qin A, Lorentzen C, Nakamura DF, Quinn KP, Sauer JM, Powell K, Ruslim L, Wright S, Chereau D, Ren Z, Anderson JP, Bard F, Yednock TA, Griswold-Prenner I.. (2011) Highly selective c-Jun N-terminal kinase (JNK) 2 and 3 inhibitors with in vitro CNS-like pharmacokinetic properties prevent neurodegeneration.. Bioorg Med Chem Lett, 21 (1): (315-319). [PMID:21112785] [10.1016/j.bmcl.2010.11.010] |
| 154. Kim MH, Kim M, Yu H, Kim H, Yoo KH, Sim T, Hah JM.. (2011) Structure based design and syntheses of amino-1H-pyrazole amide derivatives as selective Raf kinase inhibitors in melanoma cells.. Bioorg Med Chem, 19 (6): (1915-1923). [PMID:21353571] [10.1016/j.bmc.2011.01.067] |
| 155. Ren X, Duan L, He Q, Zhang Z, Zhou Y, Wu D, Pan J, Pei D, Ding K, Ding K.. (2010) Identification of Niclosamide as a New Small-Molecule Inhibitor of the STAT3 Signaling Pathway.. ACS Med Chem Lett, 1 (9): (454-459). [PMID:24900231] [10.1021/ml100146z] |
| 156. Gould AE, Adams R, Adhikari S, Aertgeerts K, Afroze R, Blackburn C, Calderwood EF, Chau R, Chouitar J, Duffey MO, England DB, Farrer C, Forsyth N, Garcia K, Gaulin J, Greenspan PD, Guo R, Harrison SJ, Huang SC, Iartchouk N, Janowick D, Kim MS, Kulkarni B, Langston SP, Liu JX, Ma LT, Menon S, Mizutani H, Paske E, Renou CC, Rezaei M, Rowland RS, Sintchak MD, Smith MD, Stroud SG, Tregay M, Tian Y, Veiby OP, Vos TJ, Vyskocil S, Williams J, Xu T, Yang JJ, Yano J, Zeng H, Zhang DM, Zhang Q, Galvin KM.. (2011) Design and optimization of potent and orally bioavailable tetrahydronaphthalene Raf inhibitors.. J Med Chem, 54 (6): (1836-1846). [PMID:21341678] [10.1021/jm101479y] |
| 157. Charrier JD, Miller A, Kay DP, Brenchley G, Twin HC, Collier PN, Ramaya S, Keily SB, Durrant SJ, Knegtel RM, Tanner AJ, Brown K, Curnock AP, Jimenez JM.. (2011) Discovery and structure-activity relationship of 3-aminopyrid-2-ones as potent and selective interleukin-2 inducible T-cell kinase (Itk) inhibitors.. J Med Chem, 54 (7): (2341-2350). [PMID:21391610] [10.1021/jm101499u] |
| 158. Okamoto M, Kojima H, Saito N, Okabe T, Masuda Y, Furuya T, Nagano T.. (2011) Virtual screening and further development of novel ALK inhibitors.. Bioorg Med Chem, 19 (10): (3086-3095). [PMID:21515061] [10.1016/j.bmc.2011.04.008] |
| 159. Lumeras W, Vidal L, Vidal B, Balagué C, Orellana A, Maldonado M, Domínguez M, Segarra V, Caturla F.. (2011) 1,7-Naphthyridine 1-oxides as novel potent and selective inhibitors of p38 mitogen activated protein kinase.. J Med Chem, 54 (22): (7899-7910). [PMID:21999461] [10.1021/jm200975u] |
| 160. Kim H, Kim M, Lee J, Yu H, Hah JM.. (2011) Syntheses of phenylpyrazolodiazepin-7-ones as conformationally rigid analogs of aminopyrazole amide scaffold and their antiproliferative effects on cancer cells.. Bioorg Med Chem, 19 (22): (6760-6767). [PMID:22014755] [10.1016/j.bmc.2011.09.042] |
| 161. Ishikawa T, Seto M, Banno H, Kawakita Y, Oorui M, Taniguchi T, Ohta Y, Tamura T, Nakayama A, Miki H, Kamiguchi H, Tanaka T, Habuka N, Sogabe S, Yano J, Aertgeerts K, Kamiyama K.. (2011) Design and synthesis of novel human epidermal growth factor receptor 2 (HER2)/epidermal growth factor receptor (EGFR) dual inhibitors bearing a pyrrolo[3,2-d]pyrimidine scaffold.. J Med Chem, 54 (23): (8030-8050). [PMID:22003817] [10.1021/jm2008634] |
| 162. Suzuki N, Shiota T, Watanabe F, Haga N, Murashi T, Ohara T, Matsuo K, Omori N, Yari H, Dohi K, Inoue M, Iguchi M, Sentou J, Wada T.. (2012) Discovery of novel 5-alkynyl-4-anilinopyrimidines as potent, orally active dual inhibitors of EGFR and Her-2 tyrosine kinases.. Bioorg Med Chem Lett, 22 (1): (456-460). [PMID:22101132] [10.1016/j.bmcl.2011.10.103] |
| 163. Powell NA, Kohrt JT, Filipski KJ, Kaufman M, Sheehan D, Edmunds JE, Delaney A, Wang Y, Bourbonais F, Lee DY, Schwende F, Sun F, McConnell P, Catana C, Chen H, Ohren J, Perrin LA.. (2012) Novel and selective spiroindoline-based inhibitors of Sky kinase.. Bioorg Med Chem Lett, 22 (1): (190-193). [PMID:22119469] [10.1016/j.bmcl.2011.11.036] |
| 164. Caruso M, Valsasina B, Ballinari D, Bertrand J, Brasca MG, Caldarelli M, Cappella P, Fiorentini F, Gianellini LM, Scolaro A, Beria I.. (2012) 5-(2-amino-pyrimidin-4-yl)-1H-pyrrole and 2-(2-amino-pyrimidin-4-yl)-1,5,6,7-tetrahydro-pyrrolo[3,2-c]pyridin-4-one derivatives as new classes of selective and orally available Polo-like kinase 1 inhibitors.. Bioorg Med Chem Lett, 22 (1): (96-101). [PMID:22154349] [10.1016/j.bmcl.2011.11.065] |
| 165. Bijian K, Zhang Z, Xu B, Jie S, Chen B, Wan S, Wu J, Jiang T, Alaoui-Jamali MA.. (2012) Synthesis and biological activity of novel organoselenium derivatives targeting multiple kinases and capable of inhibiting cancer progression to metastases.. Eur J Med Chem, 48 (143-152). [PMID:22204902] [10.1016/j.ejmech.2011.12.006] |
| 166. Gangjee A, Zaware N, Raghavan S, Yang J, Thorpe JE, Ihnat MA.. (2012) N⁴-(3-Bromophenyl)-7-(substituted benzyl) pyrrolo[2,3-d]pyrimidines as potent multiple receptor tyrosine kinase inhibitors: design, synthesis, and in vivo evaluation.. Bioorg Med Chem, 20 (7): (2444-2454). [PMID:22370340] [10.1016/j.bmc.2012.01.029] |
| 167. Cuny GD, Ulyanova NP, Patnaik D, Liu JF, Lin X, Auerbach K, Ray SS, Xian J, Glicksman MA, Stein RL, Higgins JM.. (2012) Structure-activity relationship study of beta-carboline derivatives as haspin kinase inhibitors.. Bioorg Med Chem Lett, 22 (5): (2015-2019). [PMID:22335895] [10.1016/j.bmcl.2012.01.028] |
| 168. Maryanoff BE, O'Neill JC, McComsey DF, Yabut SC, Luci DK, Jordan AD, Masucci JA, Jones WJ, Abad MC, Gibbs AC, Petrounia I.. (2011) Inhibitors of Ketohexokinase: Discovery of Pyrimidinopyrimidines with Specific Substitution that Complements the ATP-Binding Site.. ACS Med Chem Lett, 2 (7): (538-543). [PMID:24900346] [10.1021/ml200070g] |
| 169. Li WW, Wang XY, Zheng RL, Yan HX, Cao ZX, Zhong L, Wang ZR, Ji P, Yang LL, Wang LJ, Xu Y, Liu JJ, Yang J, Zhang CH, Ma S, Feng S, Sun QZ, Wei YQ, Yang SY.. (2012) Discovery of the novel potent and selective FLT3 inhibitor 1-{5-[7-(3- morpholinopropoxy)quinazolin-4-ylthio]-[1,3,4]thiadiazol-2-yl}-3-p-tolylurea and its anti-acute myeloid leukemia (AML) activities in vitro and in vivo.. J Med Chem, 55 (8): (3852-3866). [PMID:22452518] [10.1021/jm300042x] |
| 170. Lo Monte F, Kramer T, Gu J, Anumala UR, Marinelli L, La Pietra V, Novellino E, Franco B, Demedts D, Van Leuven F, Fuertes A, Dominguez JM, Plotkin B, Eldar-Finkelman H, Schmidt B.. (2012) Identification of glycogen synthase kinase-3 inhibitors with a selective sting for glycogen synthase kinase-3α.. J Med Chem, 55 (9): (4407-4424). [PMID:22533818] [10.1021/jm300309a] |
| 171. Maryanoff BE, O'Neill JC, McComsey DF, Yabut SC, Luci DK, Gibbs AC, Connelly MA.. (2012) Pyrimidinopyrimidine inhibitors of ketohexokinase: exploring the ring C2 group that interacts with Asp-27B in the ligand binding pocket.. Bioorg Med Chem Lett, 22 (16): (5326-5329). [PMID:22795331] [10.1016/j.bmcl.2012.06.008] |
| 172. Johnson SM, Murphy RC, Geiger JA, DeRocher AE, Zhang Z, Ojo KK, Larson ET, Perera BG, Dale EJ, He P, Reid MC, Fox AM, Mueller NR, Merritt EA, Fan E, Parsons M, Van Voorhis WC, Maly DJ.. (2012) Development of Toxoplasma gondii calcium-dependent protein kinase 1 (TgCDPK1) inhibitors with potent anti-toxoplasma activity.. J Med Chem, 55 (5): (2416-2426). [PMID:22320388] [10.1021/jm201713h] |
| 173. Martínez González S, Hernández AI, Varela C, Rodríguez-Arístegui S, Lorenzo M, Rodríguez A, Rivero V, Martín JI, Saluste CG, Ramos-Lima F, Cendón E, Cebrián D, Aguirre E, Gomez-Casero E, Albarrán M, Alfonso P, García-Serelde B, Oyarzabal J, Rabal O, Mulero F, Gonzalez-Granda T, Link W, Fominaya J, Barbacid M, Bischoff JR, Pizcueta P, Pastor J.. (2012) Identification of ETP-46321, a potent and orally bioavailable PI3K α, δ inhibitor.. Bioorg Med Chem Lett, 22 (10): (3460-3466). [PMID:22520259] [10.1016/j.bmcl.2012.03.090] |
| 174. Petch D, Anderson RJ, Cunningham A, George SE, Hibbs DE, Liu R, Mackay SP, Paul A, Small DA, Groundwater PW.. (2012) Design and synthesis of EGFR dimerization inhibitors and evaluation of their potential in the treatment of psoriasis.. Bioorg Med Chem, 20 (19): (5901-5914). [PMID:22944332] [10.1016/j.bmc.2012.07.048] |
| 175. Chen KF, Pao KC, Su JC, Chou YC, Liu CY, Chen HJ, Huang JW, Kim I, Shiau CW.. (2012) Development of erlotinib derivatives as CIP2A-ablating agents independent of EGFR activity.. Bioorg Med Chem, 20 (20): (6144-6153). [PMID:22980218] [10.1016/j.bmc.2012.08.039] |
| 176. Nakano H, Saito N, Parker L, Tada Y, Abe M, Tsuganezawa K, Yokoyama S, Tanaka A, Kojima H, Okabe T, Nagano T.. (2012) Rational evolution of a novel type of potent and selective proviral integration site in Moloney murine leukemia virus kinase 1 (PIM1) inhibitor from a screening-hit compound.. J Med Chem, 55 (11): (5151-5164). [PMID:22540945] [10.1021/jm3001289] |
| 177. Leahy JW, Buhr CA, Johnson HW, Kim BG, Baik T, Cannoy J, Forsyth TP, Jeong JW, Lee MS, Ma S, Noson K, Wang L, Williams M, Nuss JM, Brooks E, Foster P, Goon L, Heald N, Holst C, Jaeger C, Lam S, Lougheed J, Nguyen L, Plonowski A, Song J, Stout T, Wu X, Yakes MF, Yu P, Zhang W, Lamb P, Raeber O.. (2012) Discovery of a novel series of potent and orally bioavailable phosphoinositide 3-kinase γ inhibitors.. J Med Chem, 55 (11): (5467-5482). [PMID:22548342] [10.1021/jm300403a] |
| 178. Illig CR, Manthey CL, Wall MJ, Meegalla SK, Chen J, Wilson KJ, Ballentine SK, Desjarlais RL, Schubert C, Crysler CS, Chen Y, Molloy CJ, Chaikin MA, Donatelli RR, Yurkow E, Zhou Z, Player MR, Tomczuk BE.. (2011) Optimization of a potent class of arylamide colony-stimulating factor-1 receptor inhibitors leading to anti-inflammatory clinical candidate 4-cyano-N-[2-(1-cyclohexen-1-yl)-4-[1-[(dimethylamino)acetyl]-4-piperidinyl]phenyl]-1H-imidazole-2-carboxamide (JNJ-28312141).. J Med Chem, 54 (22): (7860-7883). [PMID:22039836] [10.1021/jm200900q] |
| 179. Chen T, Benmohamed R, Kim J, Smith K, Amante D, Morimoto RI, Kirsch DR, Ferrante RJ, Silverman RB.. (2012) ADME-guided design and synthesis of aryloxanyl pyrazolone derivatives to block mutant superoxide dismutase 1 (SOD1) cytotoxicity and protein aggregation: potential application for the treatment of amyotrophic lateral sclerosis.. J Med Chem, 55 (1): (515-527). [PMID:22191331] [10.1021/jm2014277] |
| 180. Tell V, Holzer M, Herrmann L, Mahmoud KA, Schächtele C, Totzke F, Hilgeroth A.. (2012) Multitargeted drug development: Discovery and profiling of dihydroxy substituted 1-aza-9-oxafluorenes as lead compounds targeting Alzheimer disease relevant kinases.. Bioorg Med Chem Lett, 22 (22): (6914-6918). [PMID:23039927] [10.1016/j.bmcl.2012.09.006] |
| 181. Sunose M, Bell K, Ellard K, Bergamini G, Neubauer G, Werner T, Ramsden N.. (2012) Discovery of 5-(2-amino-[1,2,4]triazolo[1,5-a]pyridin-7-yl)-N-(tert-butyl)pyridine-3-sulfonamide (CZC24758), as a potent, orally bioavailable and selective inhibitor of PI3K for the treatment of inflammatory disease.. Bioorg Med Chem Lett, 22 (14): (4613-4618). [PMID:22726925] [10.1016/j.bmcl.2012.05.090] |
| 182. Reith AD, Bamborough P, Jandu K, Andreotti D, Mensah L, Dossang P, Choi HG, Deng X, Zhang J, Alessi DR, Gray NS.. (2012) GSK2578215A; a potent and highly selective 2-arylmethyloxy-5-substitutent-N-arylbenzamide LRRK2 kinase inhibitor.. Bioorg Med Chem Lett, 22 (17): (5625-5629). [PMID:22863203] [10.1016/j.bmcl.2012.06.104] |
| 183. Amombo GM, Kramer T, Lo Monte F, Göring S, Fach M, Smith S, Kolb S, Schubenel R, Baumann K, Schmidt B.. (2012) Modification of a promiscuous inhibitor shifts the inhibition from γ-secretase to FLT-3.. Bioorg Med Chem Lett, 22 (24): (7634-7640). [PMID:23107479] [10.1016/j.bmcl.2012.10.016] |
| 184. Zhang P, Hu HR, Bian SH, Huang ZH, Chu Y, Ye DY.. (2013) Design, synthesis and biological evaluation of benzothiazepinones (BTZs) as novel non-ATP competitive inhibitors of glycogen synthase kinase-3β (GSK-3β).. Eur J Med Chem, 61 (95-103). [PMID:23047001] [10.1016/j.ejmech.2012.09.021] |
| 185. Yang LL, Li GB, Ma S, Zou C, Zhou S, Sun QZ, Cheng C, Chen X, Wang LJ, Feng S, Li LL, Yang SY.. (2013) Structure-activity relationship studies of pyrazolo[3,4-d]pyrimidine derivatives leading to the discovery of a novel multikinase inhibitor that potently inhibits FLT3 and VEGFR2 and evaluation of its activity against acute myeloid leukemia in vitro and in vivo.. J Med Chem, 56 (4): (1641-1655). [PMID:23362959] [10.1021/jm301537p] |
| 186. Gangjee A, Namjoshi OA, Yu J, Ihnat MA, Thorpe JE, Bailey-Downs LC.. (2013) N2-Trimethylacetyl substituted and unsubstituted-N4-phenylsubstituted-6-(2-pyridin-2-ylethyl)-7H-pyrrolo[2,3-d]pyrimidine-2,4-diamines: design, cellular receptor tyrosine kinase inhibitory activities and in vivo evaluation as antiangiogenic, antimetastatic and antitumor agents.. Bioorg Med Chem, 21 (5): (1312-1323). [PMID:23375090] [10.1016/j.bmc.2012.12.045] |
| 187. Gangjee A, Zaware N, Raghavan S, Disch BC, Thorpe JE, Bastian A, Ihnat MA.. (2013) Synthesis and biological activity of 5-chloro-N⁴-substituted phenyl-9H-pyrimido[4,5-b]indole-2,4-diamines as vascular endothelial growth factor receptor-2 inhibitors and antiangiogenic agents.. Bioorg Med Chem, 21 (7): (1857-1864). [PMID:23434139] [10.1016/j.bmc.2013.01.040] |
| 188. Brown A, Shi Q, Moore TW, Yoon Y, Prussia A, Maddox C, Liotta DC, Shim H, Snyder JP.. (2013) Monocarbonyl curcumin analogues: heterocyclic pleiotropic kinase inhibitors that mediate anticancer properties.. J Med Chem, 56 (9): (3456-3466). [PMID:23550937] [10.1021/jm4002692] |
| 189. Mortensen DS, Sapienza J, Lee BG, Perrin-Ninkovic SM, Harris R, Shevlin G, Parnes JS, Whitefield B, Hickman M, Khambatta G, Bisonette RR, Peng S, Gamez JC, Leisten J, Narla RK, Fultz KE, Sankar S.. (2013) Use of core modification in the discovery of CC214-2, an orally available, selective inhibitor of mTOR kinase.. Bioorg Med Chem Lett, 23 (6): (1588-1591). [PMID:23414803] [10.1016/j.bmcl.2013.01.110] |
| 190. Sanphanya K, Wattanapitayakul SK, Phowichit S, Fokin VV, Vajragupta O.. (2013) Novel VEGFR-2 kinase inhibitors identified by the back-to-front approach.. Bioorg Med Chem Lett, 23 (10): (2962-2967). [PMID:23562241] [10.1016/j.bmcl.2013.03.042] |
| 191. Han C, Huang Z, Zheng C, Wan L, Zhang L, Peng S, Ding K, Ding K, Ji H, Tian J, Zhang Y.. (2013) Novel hybrids of (phenylsulfonyl)furoxan and anilinopyrimidine as potent and selective epidermal growth factor receptor inhibitors for intervention of non-small-cell lung cancer.. J Med Chem, 56 (11): (4738-4748). [PMID:23668441] [10.1021/jm400463q] |
| 192. Pauwels D, Klaassen H, Lahortiga I, Kilonda A, Jacobs K, Sweron B, Corbau R, Chaltin P, Marchand A, Cools J.. (2013) Identification of novel FLT3 kinase inhibitors.. Eur J Med Chem, 63 (713-721). [PMID:23567961] [10.1016/j.ejmech.2013.03.024] |
| 193. Bowers S, Truong AP, Ye M, Aubele DL, Sealy JM, Neitz RJ, Hom RK, Chan W, Dappen MS, Galemmo RA, Konradi AW, Sham HL, Zhu YL, Beroza P, Tonn G, Zhang H, Hoffman J, Motter R, Fauss D, Tanaka P, Bova MP, Ren Z, Tam D, Ruslim L, Baker J, Pandya D, Diep L, Fitzgerald K, Artis DR, Anderson JP, Bergeron M.. (2013) Design and synthesis of highly selective, orally active Polo-like kinase-2 (Plk-2) inhibitors.. Bioorg Med Chem Lett, 23 (9): (2743-2749). [PMID:23522834] [10.1016/j.bmcl.2013.02.065] |
| 194. Li J, Hu H, Lang Q, Zhang H, Huang Q, Wu Y, Yu L.. (2013) A thienopyrimidine derivative induces growth inhibition and apoptosis in human cancer cell lines via inhibiting Aurora B kinase activity.. Eur J Med Chem, 65 (151-157). [PMID:23707920] [10.1016/j.ejmech.2013.04.058] |
| 195. Zhou W, Liu X, Tu Z, Zhang L, Ku X, Bai F, Zhao Z, Xu Y, Ding K, Ding K, Li H.. (2013) Discovery of pteridin-7(8H)-one-based irreversible inhibitors targeting the epidermal growth factor receptor (EGFR) kinase T790M/L858R mutant.. J Med Chem, 56 (20): (7821-7837). [PMID:24053674] [10.1021/jm401045n] |
| 196. Alder CM, Ambler M, Campbell AJ, Champigny AC, Deakin AM, Harling JD, Harris CA, Longstaff T, Lynn S, Maxwell AC, Mooney CJ, Scullion C, Singh OM, Smith IE, Somers DO, Tame CJ, Wayne G, Wilson C, Woolven JM.. (2013) Identification of a Novel and Selective Series of Itk Inhibitors via a Template-Hopping Strategy.. ACS Med Chem Lett, 4 (10): (948-952). [PMID:24900590] [10.1021/ml400206q] |
| 197. Nesi G, Sestito S, Mey V, Ricciardi S, Falasca M, Danesi R, Lapucci A, Breschi MC, Fogli S, Rapposelli S.. (2013) Synthesis of Novel 3,5-Disubstituted-2-oxindole Derivatives As Antitumor Agents against Human Nonsmall Cell Lung Cancer.. ACS Med Chem Lett, 4 (12): (1137-1141). [PMID:24900620] [10.1021/ml400162g] |
| 198. Zhang W, McIver AL, Stashko MA, DeRyckere D, Branchford BR, Hunter D, Kireev D, Miley MJ, Norris-Drouin J, Stewart WM, Lee M, Sather S, Zhou Y, Di Paola JA, Machius M, Janzen WP, Earp HS, Graham DK, Frye SV, Wang X.. (2013) Discovery of Mer specific tyrosine kinase inhibitors for the treatment and prevention of thrombosis.. J Med Chem, 56 (23): (9693-9700). [PMID:24219778] [10.1021/jm4013888] |
| 199. Sridhar J, Sfondouris ME, Bratton MR, Nguyen TL, Townley I, Klein Stevens CL, Jones FE.. (2014) Identification of quinones as HER2 inhibitors for the treatment of trastuzumab resistant breast cancer.. Bioorg Med Chem Lett, 24 (1): (126-131). [PMID:24355130] [10.1016/j.bmcl.2013.11.064] |
| 200. Haftchenary S, Luchman HA, Jouk AO, Veloso AJ, Page BD, Cheng XR, Dawson SS, Grinshtein N, Shahani VM, Kerman K, Kaplan DR, Griffin C, Aman AM, Al-Awar R, Weiss S, Gunning PT.. (2013) Potent Targeting of the STAT3 Protein in Brain Cancer Stem Cells: A Promising Route for Treating Glioblastoma.. ACS Med Chem Lett, 4 (11): (1102-1107). [PMID:24900612] [10.1021/ml4003138] |
| 201. El-Nassan HB.. (2014) Recent progress in the identification of BRAF inhibitors as anti-cancer agents.. Eur J Med Chem, 72 (170-205). [PMID:24424304] [10.1016/j.ejmech.2013.11.018] |
| 202. Cheng H, Chang Y, Zhang L, Luo J, Tu Z, Lu X, Zhang Q, Lu J, Ren X, Ding K, Ding K.. (2014) Identification and optimization of new dual inhibitors of B-Raf and epidermal growth factor receptor kinases for overcoming resistance against vemurafenib.. J Med Chem, 57 (6): (2692-2703). [PMID:24588073] [10.1021/jm500007h] |
| 203. Szokol B, Gyulavári P, Kurkó I, Baska F, Szántai-Kis C, Greff Z, Orfi Z, Peták I, Pénzes K, Torka R, Ullrich A, Orfi L, Vántus T, Kéri G.. (2014) Discovery and Biological Evaluation of Novel Dual EGFR/c-Met Inhibitors.. ACS Med Chem Lett, 5 (4): (298-303). [PMID:24900830] [10.1021/ml4003309] |
| 204. Shi Q, Tebben A, Dyckman AJ, Li H, Liu C, Lin J, Spergel S, Burke JR, McIntyre KW, Olini GC, Strnad J, Surti N, Muckelbauer JK, Chang C, An Y, Cheng L, Ruan Q, Leftheris K, Carter PH, Tino J, De Lucca GV.. (2014) Purine derivatives as potent Bruton's tyrosine kinase (BTK) inhibitors for autoimmune diseases.. Bioorg Med Chem Lett, 24 (9): (2206-2211). [PMID:24685542] [10.1016/j.bmcl.2014.02.075] |
| 205. Gogate PN, Ethirajan M, Kurenova EV, Magis AT, Pandey RK, Cance WG.. (2014) Design, synthesis, and biological evaluation of novel FAK scaffold inhibitors targeting the FAK-VEGFR3 protein-protein interaction.. Eur J Med Chem, 80 (154-166). [PMID:24780592] [10.1016/j.ejmech.2014.04.041] |
| 206. Blake JF, Gaudino JJ, De Meese J, Mohr P, Chicarelli M, Tian H, Garrey R, Thomas A, Siedem CS, Welch MB, Kolakowski G, Kaus R, Burkard M, Martinson M, Chen H, Dean B, Dudley DA, Gould SE, Pacheco P, Shahidi-Latham S, Wang W, West K, Yin J, Moffat J, Schwarz JB.. (2014) Discovery of 5,6,7,8-tetrahydropyrido[3,4-d]pyrimidine inhibitors of Erk2.. Bioorg Med Chem Lett, 24 (12): (2635-2639). [PMID:24813737] [10.1016/j.bmcl.2014.04.068] |
| 207. Zhang X, Raghavan S, Ihnat M, Thorpe JE, Disch BC, Bastian A, Bailey-Downs LC, Dybdal-Hargreaves NF, Rohena CC, Hamel E, Mooberry SL, Gangjee A.. (2014) The design and discovery of water soluble 4-substituted-2,6-dimethylfuro[2,3-d]pyrimidines as multitargeted receptor tyrosine kinase inhibitors and microtubule targeting antitumor agents.. Bioorg Med Chem, 22 (14): (3753-3772). [PMID:24890652] [10.1016/j.bmc.2014.04.049] |
| 208. Sangani CB, Makawana JA, Duan YT, Yin Y, Teraiya SB, Thumar NJ, Zhu HL.. (2014) Design, synthesis and molecular modeling of biquinoline-pyridine hybrids as a new class of potential EGFR and HER-2 kinase inhibitors.. Bioorg Med Chem Lett, 24 (18): (4472-4476). [PMID:25172421] [10.1016/j.bmcl.2014.07.094] |
| 209. Shim HJ, Yang HR, Kim HIe, Kang SA, No KT, Jung YH, Lee ST.. (2014) Discovery of (E)-5-(benzylideneamino)-1H-benzo[d]imidazol-2(3H)-one derivatives as inhibitors for PTK6.. Bioorg Med Chem Lett, 24 (19): (4659-4663). [PMID:25205190] [10.1016/j.bmcl.2014.08.036] |
| 210. Schroeder CE, Yao T, Sotsky J, Smith RA, Roy S, Chu YK, Guo H, Tower NA, Noah JW, McKellip S, Sosa M, Rasmussen L, Smith LH, White EL, Aubé J, Jonsson CB, Chung D, Golden JE.. (2014) Development of (E)-2-((1,4-dimethylpiperazin-2-ylidene)amino)-5-nitro-N-phenylbenzamide, ML336: Novel 2-amidinophenylbenzamides as potent inhibitors of venezuelan equine encephalitis virus.. J Med Chem, 57 (20): (8608-8621). [PMID:25244572] [10.1021/jm501203v] |
| 211. Scott JS, Bowker SS, Brocklehurst KJ, Brown HS, Clarke DS, Easter A, Ertan A, Goldberg K, Hudson JA, Kavanagh S, Laber D, Leach AG, MacFaul PA, Martin EA, McKerrecher D, Schofield P, Svensson PH, Teague J.. (2014) Circumventing seizure activity in a series of G protein coupled receptor 119 (GPR119) agonists.. J Med Chem, 57 (21): (8984-8998). [PMID:25286150] [10.1021/jm5011012] |
| 212. Xie F, Zhu H, Zhang H, Lang Q, Tang L, Huang Q, Yu L.. (2015) In vitro and in vivo characterization of a benzofuran derivative, a potential anticancer agent, as a novel Aurora B kinase inhibitor.. Eur J Med Chem, 89 (310-319). [PMID:25462247] [10.1016/j.ejmech.2014.10.044] |
| 213. Zhang P, Li S, Gao Y, Lu W, Huang K, Ye D, Li X, Chu Y.. (2014) Novel benzothiazinones (BTOs) as allosteric modulator or substrate competitive inhibitor of glycogen synthase kinase 3β (GSK-3β) with cellular activity of promoting glucose uptake.. Bioorg Med Chem Lett, 24 (24): (5639-5643). [PMID:25467150] [10.1016/j.bmcl.2014.10.078] |
| 214. Frett B, Brown RV, Ma M, Hu W, Han H, Li HY.. (2014) Therapeutic melting pot of never in mitosis gene a related kinase 2 (Nek2): a perspective on Nek2 as an oncology target and recent advancements in Nek2 small molecule inhibition.. J Med Chem, 57 (14): (5835-5844). [PMID:24517277] [10.1021/jm401719n] |
| 215. Song Z, Yang Y, Liu Z, Peng X, Guo J, Yang X, Wu K, Ai J, Ding J, Geng M, Zhang A.. (2015) Discovery of novel 2,4-diarylaminopyrimidine analogues (DAAPalogues) showing potent inhibitory activities against both wild-type and mutant ALK kinases.. J Med Chem, 58 (1): (197-211). [PMID:24785465] [10.1021/jm5005144] |
| 216. Horbert R, Pinchuk B, Johannes E, Schlosser J, Schmidt D, Cappel D, Totzke F, Schächtele C, Peifer C.. (2015) Optimization of potent DFG-in inhibitors of platelet derived growth factor receptorβ (PDGF-Rβ) guided by water thermodynamics.. J Med Chem, 58 (1): (170-182). [PMID:25007344] [10.1021/jm500373x] |
| 217. Muth F, Günther M, Bauer SM, Döring E, Fischer S, Maier J, Drückes P, Köppler J, Trappe J, Rothbauer U, Koch P, Laufer SA.. (2015) Tetra-substituted pyridinylimidazoles as dual inhibitors of p38α mitogen-activated protein kinase and c-Jun N-terminal kinase 3 for potential treatment of neurodegenerative diseases.. J Med Chem, 58 (1): (443-456). [PMID:25475894] [10.1021/jm501557a] |
| 218. Mathew MP, Tan E, Saeui CT, Bovonratwet P, Liu L, Bhattacharya R, Yarema KJ.. (2015) Metabolic glycoengineering sensitizes drug-resistant pancreatic cancer cells to tyrosine kinase inhibitors erlotinib and gefitinib.. Bioorg Med Chem Lett, 25 (6): (1223-1227). [PMID:25690786] [10.1016/j.bmcl.2015.01.060] |
| 219. Wada K, Lee JY, Hung HY, Shi Q, Lin L, Zhao Y, Goto M, Yang PC, Kuo SC, Chen HW, Lee KH.. (2015) Novel curcumin analogs to overcome EGFR-TKI lung adenocarcinoma drug resistance and reduce EGFR-TKI-induced GI adverse effects.. Bioorg Med Chem, 23 (7): (1507-1514). [PMID:25753330] [10.1016/j.bmc.2015.02.003] |
| 220. Zhang X, Raghavan S, Ihnat M, Hamel E, Zammiello C, Bastian A, Mooberry SL, Gangjee A.. (2015) The design, synthesis and biological evaluation of conformationally restricted 4-substituted-2,6-dimethylfuro[2,3-d]pyrimidines as multi-targeted receptor tyrosine kinase and microtubule inhibitors as potential antitumor agents.. Bioorg Med Chem, 23 (10): (2408-2423). [PMID:25882519] [10.1016/j.bmc.2015.03.061] |
| 221. Lawrence HR, Mahajan K, Luo Y, Zhang D, Tindall N, Huseyin M, Gevariya H, Kazi S, Ozcan S, Mahajan NP, Lawrence NJ.. (2015) Development of novel ACK1/TNK2 inhibitors using a fragment-based approach.. J Med Chem, 58 (6): (2746-2763). [PMID:25699576] [10.1021/jm501929n] |
| 222. Kovackova S, Chang L, Bekerman E, Neveu G, Barouch-Bentov R, Chaikuad A, Heroven C, Šála M, De Jonghe S, Knapp S, Einav S, Herdewijn P.. (2015) Selective Inhibitors of Cyclin G Associated Kinase (GAK) as Anti-Hepatitis C Agents.. J Med Chem, 58 (8): (3393-3410). [PMID:25822739] [10.1021/jm501759m] |
| 223. Zhang CH, Zheng MW, Li YP, Lin XD, Huang M, Zhong L, Li GB, Zhang RJ, Lin WT, Jiao Y, Wu XA, Yang J, Xiang R, Chen LJ, Zhao YL, Cheng W, Wei YQ, Yang SY.. (2015) Design, Synthesis, and Structure-Activity Relationship Studies of 3-(Phenylethynyl)-1H-pyrazolo[3,4-d]pyrimidin-4-amine Derivatives as a New Class of Src Inhibitors with Potent Activities in Models of Triple Negative Breast Cancer.. J Med Chem, 58 (9): (3957-3974). [PMID:25835317] [10.1021/acs.jmedchem.5b00270] |
| 224. Tintori C, La Sala G, Vignaroli G, Botta L, Fallacara AL, Falchi F, Radi M, Zamperini C, Dreassi E, Dello Iacono L, Orioli D, Biamonti G, Garbelli M, Lossani A, Gasparrini F, Tuccinardi T, Laurenzana I, Angelucci A, Maga G, Schenone S, Brullo C, Musumeci F, Desogus A, Crespan E, Botta M.. (2015) Studies on the ATP Binding Site of Fyn Kinase for the Identification of New Inhibitors and Their Evaluation as Potential Agents against Tauopathies and Tumors.. J Med Chem, 58 (11): (4590-4609). [PMID:25923950] [10.1021/acs.jmedchem.5b00140] |
| 225. Tan L, Akahane K, McNally R, Reyskens KM, Ficarro SB, Liu S, Herter-Sprie GS, Koyama S, Pattison MJ, Labella K, Johannessen L, Akbay EA, Wong KK, Frank DA, Marto JA, Look TA, Arthur JS, Eck MJ, Gray NS.. (2015) Development of Selective Covalent Janus Kinase 3 Inhibitors.. J Med Chem, 58 (16): (6589-6606). [PMID:26258521] [10.1021/acs.jmedchem.5b00710] |
| 226. Engel J, Richters A, Getlik M, Tomassi S, Keul M, Termathe M, Lategahn J, Becker C, Mayer-Wrangowski S, Grütter C, Uhlenbrock N, Krüll J, Schaumann N, Eppmann S, Kibies P, Hoffgaard F, Heil J, Menninger S, Ortiz-Cuaran S, Heuckmann JM, Tinnefeld V, Zahedi RP, Sos ML, Schultz-Fademrecht C, Thomas RK, Kast SM, Rauh D.. (2015) Targeting Drug Resistance in EGFR with Covalent Inhibitors: A Structure-Based Design Approach.. J Med Chem, 58 (17): (6844-6863). [PMID:26275028] [10.1021/acs.jmedchem.5b01082] |
| 227. Diez-Cecilia E, Carson R, Kelly B, van Schaeybroeck S, Murray JT, Rozas I.. (2015) Probing a 3,4'-bis-guanidinium diaryl derivative as an allosteric inhibitor of the Ras pathway.. Bioorg Med Chem Lett, 25 (19): (4287-4292). [PMID:26318998] [10.1016/j.bmcl.2015.07.082] |
| 228. Lin XD, Yang HW, Ma S, Li WW, Zhang CH, Wang WJ, Xiang R, Li LL, Yang SY.. (2015) Discovery of 6-phenylimidazo[2,1-b]thiazole derivatives as a new type of FLT3 inhibitors.. Bioorg Med Chem Lett, 25 (20): (4534-4538). [PMID:26342867] [10.1016/j.bmcl.2015.08.068] |
| 229. Charnley AK, Convery MA, Lakdawala Shah A, Jones E, Hardwicke P, Bridges A, Ouellette M, Totoritis R, Schwartz B, King BW, Wisnoski DD, Kang J, Eidam PM, Votta BJ, Gough PJ, Marquis RW, Bertin J, Casillas L.. (2015) Crystal structures of human RIP2 kinase catalytic domain complexed with ATP-competitive inhibitors: Foundations for understanding inhibitor selectivity.. Bioorg Med Chem, 23 (21): (7000-7006). [PMID:26455654] [10.1016/j.bmc.2015.09.038] |
| 230. Ravez S, Arsenlis S, Barczyk A, Dupont A, Frédérick R, Hesse S, Kirsch G, Depreux P, Goossens L.. (2015) Synthesis and biological evaluation of di-aryl urea derivatives as c-Kit inhibitors.. Bioorg Med Chem, 23 (22): (7340-7347). [PMID:26526740] [10.1016/j.bmc.2015.10.035] |
| 231. Elkamhawy A, Farag AK, Viswanath AN, Bedair TM, Leem DG, Lee KT, Pae AN, Roh EJ.. (2015) Targeting EGFR/HER2 tyrosine kinases with a new potent series of 6-substituted 4-anilinoquinazoline hybrids: Design, synthesis, kinase assay, cell-based assay, and molecular docking.. Bioorg Med Chem Lett, 25 (22): (5147-5154). [PMID:26475520] [10.1016/j.bmcl.2015.10.003] |
| 232. Nakano H, Hasegawa T, Saito N, Furukawa K, Mukaida N, Kojima H, Okabe T, Nagano T.. (2015) Design and synthesis of an in vivo-efficacious PIM3 kinase inhibitor as a candidate anti-pancreatic cancer agent.. Bioorg Med Chem Lett, 25 (24): (5687-5693). [PMID:26547690] [10.1016/j.bmcl.2015.10.098] |
| 233. Qin M, Wang T, Xu B, Ma Z, Jiang N, Xie H, Gong P, Zhao Y.. (2015) Novel hydrazone moiety-bearing aminopyrimidines as selective inhibitors of epidermal growth factor receptor T790M mutant.. Eur J Med Chem, 104 (115-126). [PMID:26451770] [10.1016/j.ejmech.2015.09.031] |
| 234. Li X, Wang A, Yu K, Qi Z, Chen C, Wang W, Hu C, Wu H, Wu J, Zhao Z, Liu J, Zou F, Wang L, Wang B, Wang W, Zhang S, Liu J, Liu Q.. (2015) Discovery of (R)-1-(3-(4-Amino-3-(4-phenoxyphenyl)-1H-pyrazolo[3,4-d]pyrimidin-1-yl)piperidin-1-yl)-2-(dimethylamino)ethanone (CHMFL-FLT3-122) as a Potent and Orally Available FLT3 Kinase Inhibitor for FLT3-ITD Positive Acute Myeloid Leukemia.. J Med Chem, 58 (24): (9625-9638). [PMID:26630553] [10.1021/acs.jmedchem.5b01611] |
| 235. Shan Y, Wang C, Zhang L, Wang J, Wang M, Dong Y.. (2016) Expanding the structural diversity of diarylureas as multi-target tyrosine kinase inhibitors.. Bioorg Med Chem, 24 (4): (750-758). [PMID:26753815] [10.1016/j.bmc.2015.12.038] |
| 236. Zhang HQ, Gong FH, Li CG, Zhang C, Wang YJ, Xu YG, Sun LP.. (2016) Design and discovery of 4-anilinoquinazoline-acylamino derivatives as EGFR and VEGFR-2 dual TK inhibitors.. Eur J Med Chem, 109 (371-379). [PMID:26826581] [10.1016/j.ejmech.2015.12.032] |
| 237. Aman W, Lee J, Kim M, Yang S, Jung H, Hah JM.. (2016) Discovery of highly selective CRAF inhibitors, 3-carboxamido-2H-indazole-6-arylamide: In silico FBLD design, synthesis and evaluation.. Bioorg Med Chem Lett, 26 (4): (1188-1192). [PMID:26810260] [10.1016/j.bmcl.2016.01.037] |
| 238. Yu H, Li Y, Ge Y, Song Z, Wang C, Huang S, Jin Y, Han X, Zhen Y, Liu K, Zhou Y, Ma X.. (2016) Novel 4-anilinoquinazoline derivatives featuring an 1-adamantyl moiety as potent EGFR inhibitors with enhanced activity against NSCLC cell lines.. Eur J Med Chem, 110 (195-203). [PMID:26829280] [10.1016/j.ejmech.2016.01.045] |
| 239. Huard K, Gosset JR, Montgomery JI, Gilbert A, Hayward MM, Magee TV, Cabral S, Uccello DP, Bahnck K, Brown J, Purkal J, Gorgoglione M, Lanba A, Futatsugi K, Herr M, Genung NE, Aspnes G, Polivkova J, Garcia-Irizarry CN, Li Q, Canterbury D, Niosi M, Vera NB, Li Z, Khunte B, Siderewicz J, Rolph T, Erion DM.. (2016) Optimization of a Dicarboxylic Series for in Vivo Inhibition of Citrate Transport by the Solute Carrier 13 (SLC13) Family.. J Med Chem, 59 (3): (1165-1175). [PMID:26734723] [10.1021/acs.jmedchem.5b01752] |
| 240. Schiemann K, Mallinger A, Wienke D, Esdar C, Poeschke O, Busch M, Rohdich F, Eccles SA, Schneider R, Raynaud FI, Czodrowski P, Musil D, Schwarz D, Urbahns K, Blagg J.. (2016) Discovery of potent and selective CDK8 inhibitors from an HSP90 pharmacophore.. Bioorg Med Chem Lett, 26 (5): (1443-1451). [PMID:26852363] [10.1016/j.bmcl.2016.01.062] |
| 241. Mariano M, Hartmann RW, Engel M.. (2016) Systematic diversification of benzylidene heterocycles yields novel inhibitor scaffolds selective for Dyrk1A, Clk1 and CK2.. Eur J Med Chem, 112 (209-216). [PMID:26896709] [10.1016/j.ejmech.2016.02.017] |
| 242. Song D, Lee M, Park CH, Ahn S, Yun CS, Lee CO, Kim HR, Hwang JY.. (2016) Novel 2,4-diaminopyrimidines bearing tetrahydronaphthalenyl moiety against anaplastic lymphoma kinase (ALK): Synthesis, in vitro, ex vivo, and in vivo efficacy studies.. Bioorg Med Chem Lett, 26 (7): (1720-1725). [PMID:26923695] [10.1016/j.bmcl.2016.02.052] |
| 243. Park D, Ha IJ, Park SY, Choi M, Lim SL, Kim SH, Lee JH, Ahn KS, Yun M, Lee SG.. (2016) Morusin Induces TRAIL Sensitization by Regulating EGFR and DR5 in Human Glioblastoma Cells.. J Nat Prod, 79 (2): (317-323). [PMID:26829656] [10.1021/acs.jnatprod.5b00919] |
| 244. Sweidan K, Sabbah DA, Bardaweel S, Dush KA, Sheikha GA, Mubarak MS.. (2016) Computer-aided design, synthesis, and biological evaluation of new indole-2-carboxamide derivatives as PI3Kα/EGFR inhibitors.. Bioorg Med Chem Lett, 26 (11): (2685-2690). [PMID:27084677] [10.1016/j.bmcl.2016.04.011] |
| 245. Jung ME, Byun BJ, Kim HM, Lee JY, Park JH, Lee N, Son YH, Choi SU, Yang KM, Kim SJ, Lee K, Kim YC, Choi G.. (2016) Discovery of indirubin derivatives as new class of DRAK2 inhibitors from high throughput screening.. Bioorg Med Chem Lett, 26 (11): (2719-2723). [PMID:27106709] [10.1016/j.bmcl.2016.03.111] |
| 246. Daydé-Cazals B, Fauvel B, Singer M, Feneyrolles C, Bestgen B, Gassiot F, Spenlinhauer A, Warnault P, Van Hijfte N, Borjini N, Chevé G, Yasri A.. (2016) Rational Design, Synthesis, and Biological Evaluation of 7-Azaindole Derivatives as Potent Focused Multi-Targeted Kinase Inhibitors.. J Med Chem, 59 (8): (3886-3905). [PMID:27010810] [10.1021/acs.jmedchem.6b00087] |
| 247. Schroeder RL, Goyal N, Bratton M, Townley I, Pham NA, Tram P, Stone T, Geathers J, Nguyen K, Sridhar J.. (2016) Identification of quinones as novel PIM1 kinase inhibitors.. Bioorg Med Chem Lett, 26 (13): (3187-3191). [PMID:27173800] [10.1016/j.bmcl.2016.04.079] |
| 248. Yin S, Tang C, Wang B, Zhang Y, Zhou L, Xue L, Zhang C.. (2016) Design, synthesis and biological evaluation of novel EGFR/HER2 dual inhibitors bearing a oxazolo[4,5-g]quinazolin-2(1H)-one scaffold.. Eur J Med Chem, 120 (26-36). [PMID:27187856] [10.1016/j.ejmech.2016.04.072] |
| 249. Kim H, Lee C, Yang JS, Choi S, Park CH, Kang JS, Oh SJ, Yun J, Kim MH, Han G.. (2016) Structural modifications at the 6-position of thieno[2,3-d]pyrimidines and their effects on potency at FLT3 for treatment of acute myeloid leukemia.. Eur J Med Chem, 120 (74-85). [PMID:27187860] [10.1016/j.ejmech.2016.05.022] |
| 250. Musumeci F, Fallacara AL, Brullo C, Grossi G, Botta L, Calandro P, Chiariello M, Kissova M, Crespan E, Maga G, Schenone S.. (2017) Identification of new pyrrolo[2,3-d]pyrimidines as Src tyrosine kinase inhibitors in vitro active against Glioblastoma.. Eur J Med Chem, 127 (369-378). [PMID:28076826] [10.1016/j.ejmech.2016.12.036] |
| 251. Chen Y, Zheng Y, Jiang Q, Qin F, Zhang Y, Fu L, He G.. (2017) Integrated bioinformatics, computational and experimental methods to discover novel Raf/extracellular-signal regulated kinase (ERK) dual inhibitors against breast cancer cells.. Eur J Med Chem, 127 (997-1011). [PMID:27839788] [10.1016/j.ejmech.2016.11.009] |
| 252. Pavana RK, Choudhary S, Bastian A, Ihnat MA, Bai R, Hamel E, Gangjee A.. (2017) Discovery and preclinical evaluation of 7-benzyl-N-(substituted)-pyrrolo[3,2-d]pyrimidin-4-amines as single agents with microtubule targeting effects along with triple-acting angiokinase inhibition as antitumor agents.. Bioorg Med Chem, 25 (2): (545-556). [PMID:27894589] [10.1016/j.bmc.2016.11.026] |
| 253. Argyros O, Lougiakis N, Kouvari E, Papafotika A, Raptopoulou CP, Psycharis V, Christoforidis S, Pouli N, Marakos P, Tamvakopoulos C.. (2017) Design and synthesis of novel 7-aminosubstituted pyrido[2,3-b]pyrazines exhibiting anti-breast cancer activity.. Eur J Med Chem, 126 (954-968). [PMID:28006668] [10.1016/j.ejmech.2016.12.025] |
| 254. Shi Y, Park J, Lagisetti C, Zhou W, Sambucetti LC, Webb TR.. (2017) A triple exon-skipping luciferase reporter assay identifies a new CLK inhibitor pharmacophore.. Bioorg Med Chem Lett, 27 (3): (406-412). [PMID:28049589] [10.1016/j.bmcl.2016.12.056] |
| 255. Hoemann M, Wilson N, Argiriadi M, Banach D, Burchat A, Calderwood D, Clapham B, Cox P, Duignan DB, Konopacki D, Somal G, Vasudevan A.. (2016) Synthesis and optimization of furano[3,2-d]pyrimidines as selective spleen tyrosine kinase (Syk) inhibitors.. Bioorg Med Chem Lett, 26 (22): (5562-5567). [PMID:27789138] [10.1016/j.bmcl.2016.09.077] |
| 256. Ma F, Liu P, Lei M, Liu J, Wang H, Zhao S, Hu L.. (2017) Design, synthesis and biological evaluation of indolin-2-one-based derivatives as potent, selective and efficacious inhibitors of FMS-like tyrosine kinase3 (FLT3).. Eur J Med Chem, 127 (72-86). [PMID:28038328] [10.1016/j.ejmech.2016.12.038] |
| 257. Ebrahim HY,Mohyeldin MM,Hailat MM,El Sayed KA. (2016) (1S,2E,4S,7E,11E)-2,7,11-Cembratriene-4,6-diol semisynthetic analogs as novel c-Met inhibitors for the control of c-Met-dependent breast malignancies.. Bioorg Med Chem, 24 (22.0): (5748-5761). [PMID:27681240] [10.1016/j.bmc.2016.09.032] |
| 258. Margolis, B L BL and 8 more authors.. (1989) All autophosphorylation sites of epidermal growth factor (EGF) receptor and HER2/neu are located in their carboxyl-terminal tails. Identification of a novel site in EGF receptor.. The Journal of biological chemistry, (25): [PMID:2543678] |
| 259. Chen, W S WS and 9 more authors.. (1989) Functional independence of the epidermal growth factor receptor from a domain required for ligand-induced internalization and calcium regulation.. Cell, (6): [PMID:2790960] |
| 260. Russo, M W MW, Lukas, T J TJ, Cohen, S S and Staros, J V JV.. (1985) Identification of residues in the nucleotide binding site of the epidermal growth factor receptor/kinase.. The Journal of biological chemistry, (10): [PMID:2985580] |
| 261. and Carpenter, G G.. (1987) Receptors for epidermal growth factor and other polypeptide mitogens.. Annual review of biochemistry, [PMID:3039909] |
| 262. Heisermann, G J GJ and Gill, G N GN.. (1988) Epidermal growth factor receptor threonine and serine residues phosphorylated in vivo.. The Journal of biological chemistry, (15): [PMID:3138233] |
| 263. Haley, J J and 5 more authors.. The human EGF receptor gene: structure of the 110 kb locus and identification of sequences regulating its transcription.. Oncogene research, [PMID:3329716] |
| 264. Weber, W W, Gill, G N GN and Spiess, J J.. (1984) Production of an epidermal growth factor receptor-related protein.. Science (New York, N.Y.), (20): [PMID:6324343] |
| 265. Mroczkowski, B B, Mosig, G G and Cohen, S S.. (1984) ATP-stimulated interaction between epidermal growth factor receptor and supercoiled DNA.. Nature, [PMID:6325948] |
| 266. Ullrich, A A and 9 more authors.. (1984) Human epidermal growth factor receptor cDNA sequence and aberrant expression of the amplified gene in A431 epidermoid carcinoma cells.. Nature, [PMID:6328312] |
| 267. Xu, Y H YH and 8 more authors.. (1984) Human epidermal growth factor receptor cDNA is homologous to a variety of RNAs overproduced in A431 carcinoma cells.. Nature, [PMID:6330563] |
| 268. Ilekis, J V JV, Stark, B C BC and Scoccia, B B.. (1995) Possible role of variant RNA transcripts in the regulation of epidermal growth factor receptor expression in human placenta.. Molecular reproduction and development, [PMID:7654368] |
| 269. Galisteo, M L ML, Dikic, I I, Batzer, A G AG, Langdon, W Y WY and Schlessinger, J J.. (1995) Tyrosine phosphorylation of the c-cbl proto-oncogene protein product and association with epidermal growth factor (EGF) receptor upon EGF stimulation.. The Journal of biological chemistry, (1): [PMID:7657591] |
| 270. Watanabe, T T and 6 more authors.. (1994) Recombinant human betacellulin. Molecular structure, biological activities, and receptor interaction.. The Journal of biological chemistry, (1): [PMID:8144591] |
| 271. Reiter, J L JL and Maihle, N J NJ.. (1996) A 1.8 kb alternative transcript from the human epidermal growth factor receptor gene encodes a truncated form of the receptor.. Nucleic acids research, (15): [PMID:8918811] |
| 272. Smith, K D KD, Davies, M J MJ, Bailey, D D, Renouf, D V DV and Hounsell, E F EF.. (1996) Analysis of the glycosylation patterns of the extracellular domain of the epidermal growth factor receptor expressed in Chinese hamster ovary fibroblasts.. Growth factors (Chur, Switzerland), [PMID:8962717] |
| 273. Ilekis, J V JV, Gariti, J J, Niederberger, C C and Scoccia, B B.. (1997) Expression of a truncated epidermal growth factor receptor-like protein (TEGFR) in ovarian cancer.. Gynecologic oncology, [PMID:9103388] |
| 274. Tiganis, T T, Bennett, A M AM, Ravichandran, K S KS and Tonks, N K NK.. (1998) Epidermal growth factor receptor and the adaptor protein p52Shc are specific substrates of T-cell protein tyrosine phosphatase.. Molecular and cellular biology, [PMID:9488479] |
| 275. Gangwani, L L, Mikrut, M M, Galcheva-Gargova, Z Z and Davis, R J RJ.. (1998) Interaction of ZPR1 with translation elongation factor-1alpha in proliferating cells.. The Journal of cell biology, (14): [PMID:9852145] |
| 276. Braverman, L E LE and Quilliam, L A LA.. (1999) Identification of Grb4/Nckbeta, a src homology 2 and 3 domain-containing adapter protein having similar binding and biological properties to Nck.. The Journal of biological chemistry, (26): [PMID:10026169] |
| 277. Bagowski, C P CP, Stein-Gerlach, M M, Choidas, A A and Ullrich, A A.. (1999) Cell-type specific phosphorylation of threonines T654 and T669 by PKD defines the signal capacity of the EGF receptor.. The EMBO journal, (15): [PMID:10523301] |
| 278. Sato, C C and 5 more authors.. (2000) Characterization of the N-oligosaccharides attached to the atypical Asn-X-Cys sequence of recombinant human epidermal growth factor receptor.. Journal of biochemistry, [PMID:10731668] |
| 279. Habib, A A AA and 5 more authors.. (2001) The epidermal growth factor receptor engages receptor interacting protein and nuclear factor-kappa B (NF-kappa B)-inducing kinase to activate NF-kappa B. Identification of a novel receptor-tyrosine kinase signalosome.. The Journal of biological chemistry, (23): [PMID:11116146] |
| 280. Yang, X D XD, Jia, X C XC, Corvalan, J R JR, Wang, P P and Davis, C G CG.. (2001) Development of ABX-EGF, a fully human anti-EGF receptor monoclonal antibody, for cancer therapy.. Critical reviews in oncology/hematology, [PMID:11255078] |
| 281. Moasser, M M MM, Basso, A A, Averbuch, S D SD and Rosen, N N.. (2001) The tyrosine kinase inhibitor ZD1839 ("Iressa") inhibits HER2-driven signaling and suppresses the growth of HER2-overexpressing tumor cells.. Cancer research, (1): [PMID:11585753] |
| 282. Chen, X X, Ji, Z L ZL and Chen, Y Z YZ.. (2002) TTD: Therapeutic Target Database.. Nucleic acids research, (1): [PMID:11752352] |
| 283. Garrett, Thomas P J TP and 13 more authors.. (2002) Crystal structure of a truncated epidermal growth factor receptor extracellular domain bound to transforming growth factor alpha.. Cell, (20): [PMID:12297049] |
| 284. Laird, A Douglas AD and Cherrington, Julie M JM.. (2003) Small molecule tyrosine kinase inhibitors: clinical development of anticancer agents.. Expert opinion on investigational drugs, [PMID:12517254] |
| 285. Ferguson, Kathryn M KM and 5 more authors.. (2003) EGF activates its receptor by removing interactions that autoinhibit ectodomain dimerization.. Molecular cell, [PMID:12620237] |
| 286. Akita, Robert W RW and Sliwkowski, Mark X MX.. (2003) Preclinical studies with Erlotinib (Tarceva).. Seminars in oncology, [PMID:12840797] |
| 287. Shao, Huang H, Cheng, Haiyun Y HY, Cook, Richard G RG and Tweardy, David J DJ.. (2003) Identification and characterization of signal transducer and activator of transcription 3 recruitment sites within the epidermal growth factor receptor.. Cancer research, (15): [PMID:12873986] |
| 288. Xia, Wenle W, Liu, Lei-Hua LH, Ho, Peter P and Spector, Neil L NL.. (2004) Truncated ErbB2 receptor (p95ErbB2) is regulated by heregulin through heterodimer formation with ErbB3 yet remains sensitive to the dual EGFR/ErbB2 kinase inhibitor GW572016.. Oncogene, (22): [PMID:14737100] |
| 289. Paez, J Guillermo JG and 16 more authors.. (2004) EGFR mutations in lung cancer: correlation with clinical response to gefitinib therapy.. Science (New York, N.Y.), (4): [PMID:15118125] |
| 290. and Burris, Howard A HA.. (2004) Dual kinase inhibition in the treatment of breast cancer: initial experience with the EGFR/ErbB-2 inhibitor lapatinib.. The oncologist, [PMID:15163842] |
| 291. Zhang, Zemin Z and Henzel, William J WJ.. (2004) Signal peptide prediction based on analysis of experimentally verified cleavage sites.. Protein science : a publication of the Protein Society, [PMID:15340161] |
| 292. Kario, Edith E and 7 more authors.. (2005) Suppressors of cytokine signaling 4 and 5 regulate epidermal growth factor receptor signaling.. The Journal of biological chemistry, (25): [PMID:15590694] |
| 293. Kochupurakkal, Bose S BS and 15 more authors.. (2005) Epigen, the last ligand of ErbB receptors, reveals intricate relationships between affinity and mitogenicity.. The Journal of biological chemistry, (4): [PMID:15611079] |
| 294. Huang, Shiu-Feng SF and 12 more authors.. (2004) High frequency of epidermal growth factor receptor mutations with complex patterns in non-small cell lung cancers related to gefitinib responsiveness in Taiwan.. Clinical cancer research : an official journal of the American Association for Cancer Research, (15): [PMID:15623594] |
| 295. Harding, Joanne J and Burtness, Barbara B.. (2005) Cetuximab: an epidermal growth factor receptor chemeric human-murine monoclonal antibody.. Drugs of today (Barcelona, Spain : 1998), [PMID:15821783] |
| 296. Wu, Shiaw-Lin SL, Kim, Jeongkwon J, Hancock, William S WS and Karger, Barry B.. Extended Range Proteomic Analysis (ERPA): a new and sensitive LC-MS platform for high sequence coverage of complex proteins with extensive post-translational modifications-comprehensive analysis of beta-casein and epidermal growth factor receptor (EGFR).. Journal of proteome research, [PMID:16083266] |
| 297. Vadlamudi, Ratna K RK and 6 more authors.. (2005) Functional implications of altered subcellular localization of PELP1 in breast cancer cells.. Cancer research, (1): [PMID:16140940] |
| 298. Huang, Fangtian F, Kirkpatrick, Donald D, Jiang, Xuejun X, Gygi, Steven S and Sorkin, Alexander A.. (2006) Differential regulation of EGF receptor internalization and degradation by multiubiquitination within the kinase domain.. Molecular cell, (17): [PMID:16543144] |
| 299. Ji, Hongbin H and 23 more authors.. (2006) Epidermal growth factor receptor variant III mutations in lung tumorigenesis and sensitivity to tyrosine kinase inhibitors.. Proceedings of the National Academy of Sciences of the United States of America, (16): [PMID:16672372] |
| 300. Johnston, Stephen R D SR and Leary, Alex A.. (2006) Lapatinib: a novel EGFR/HER2 tyrosine kinase inhibitor for cancer.. Drugs of today (Barcelona, Spain : 1998), [PMID:16894399] |
| 301. Farhan, Hesso H and 9 more authors.. (2006) Inhibition of xenograft tumor growth and down-regulation of ErbB receptors by an antibody directed against Lewis Y antigen.. The Journal of pharmacology and experimental therapeutics, [PMID:16963623] |
| 302. Wang, Shao-Chun SC and 10 more authors.. (2006) Tyrosine phosphorylation controls PCNA function through protein stability.. Nature cell biology, [PMID:17115032] |
| 303. Shen, Feng F, Lin, Qiong Q, Gu, Yan Y, Childress, Chandra C and Yang, Wannian W.. (2007) Activated Cdc42-associated kinase 1 is a component of EGF receptor signaling complex and regulates EGF receptor degradation.. Molecular biology of the cell, [PMID:17182860] |
| 304. Wada, T T and 6 more authors.. (2007) A crucial role of plasma membrane-associated sialidase in the survival of human cancer cells.. Oncogene, (12): [PMID:17334392] |
| 305. Yun, Cai-Hong CH and 6 more authors.. (2007) Structures of lung cancer-derived EGFR mutants and inhibitor complexes: mechanism of activation and insights into differential inhibitor sensitivity.. Cancer cell, [PMID:17349580] |
| 306. Groenestege, Wouter M Tiel WM and 10 more authors.. (2007) Impaired basolateral sorting of pro-EGF causes isolated recessive renal hypomagnesemia.. The Journal of clinical investigation, [PMID:17671655] |
| 307. Kim, Jayoung J and 7 more authors.. (2007) The phosphoinositide kinase PIKfyve mediates epidermal growth factor receptor trafficking to the nucleus.. Cancer research, (1): [PMID:17909029] |
| 308. Nonis, David D and 6 more authors.. (2008) Ataxin-2 associates with the endocytosis complex and affects EGF receptor trafficking.. Cellular signalling, [PMID:18602463] |
| 309. Dephoure, Noah N and 6 more authors.. (2008) A quantitative atlas of mitotic phosphorylation.. Proceedings of the National Academy of Sciences of the United States of America, (5): [PMID:18669648] |
| 310. Daub, Henrik H and 9 more authors.. (2008) Kinase-selective enrichment enables quantitative phosphoproteomics of the kinome across the cell cycle.. Molecular cell, (8): [PMID:18691976] |
| 311. Medina, Patrick J PJ and Goodin, Susan S.. (2008) Lapatinib: a dual inhibitor of human epidermal growth factor receptor tyrosine kinases.. Clinical therapeutics, [PMID:18803986] |
| 312. Brummer, Tilman T and 11 more authors.. (2008) Phosphorylation-dependent binding of 14-3-3 terminates signalling by the Gab2 docking protein.. The EMBO journal, (3): [PMID:19172738] |
| 313. Sardon, Teresa T, Cottin, Thomas T, Xu, Jing J, Giannis, Athanassios A and Vernos, Isabelle I.. (2009) Development and biological evaluation of a novel aurora A kinase inhibitor.. Chembiochem : a European journal of chemical biology, (13): [PMID:19199284] |
| 314. Tashiro, Kyoko K and 7 more authors.. (2009) GAREM, a novel adaptor protein for growth factor receptor-bound protein 2, contributes to cellular transformation through the activation of extracellular signal-regulated kinase signaling.. The Journal of biological chemistry, (24): [PMID:19509291] |
| 315. Red Brewer, Monica and 6 more authors.. (2009) The juxtamembrane region of the EGF receptor functions as an activation domain.. Molecular cell, (26): [PMID:19560417] |
| 316. Jura, Natalia N and 8 more authors.. (2009) Mechanism for activation of the EGF receptor catalytic domain by the juxtamembrane segment.. Cell, (26): [PMID:19563760] |
| 317. Alvarado, Diego D, Klein, Daryl E DE and Lemmon, Mark A MA.. (2009) ErbB2 resembles an autoinhibited invertebrate epidermal growth factor receptor.. Nature, (10): [PMID:19718021] |
| 318. Vivacqua, Adele A and 8 more authors.. (2009) G protein-coupled receptor 30 expression is up-regulated by EGF and TGF alpha in estrogen receptor alpha-positive cancer cells.. Molecular endocrinology (Baltimore, Md.), [PMID:19749156] |
| 319. Tevaarwerk, Amye J AJ and Kolesar, Jill M JM.. (2009) Lapatinib: a small-molecule inhibitor of epidermal growth factor receptor and human epidermal growth factor receptor-2 tyrosine kinases used in the treatment of breast cancer.. Clinical therapeutics, [PMID:20110044] |
| 320. Garofalo, Antonio A and 5 more authors.. (2010) Quinazoline-urea, new protein kinase inhibitors in treatment of prostate cancer.. Journal of enzyme inhibition and medicinal chemistry, [PMID:20222760] |
| 321. Ghosh, Pradipta P and 10 more authors.. (2010) A G{alpha}i-GIV molecular complex binds epidermal growth factor receptor and determines whether cells migrate or proliferate.. Molecular biology of the cell, (1): [PMID:20462955] |
| 322. Mineev, Konstantin S KS and 5 more authors.. (2010) Spatial structure of the transmembrane domain heterodimer of ErbB1 and ErbB2 receptor tyrosine kinases.. Journal of molecular biology, (9): [PMID:20471394] |
| 323. and Keating, Gillian M GM.. (2010) Panitumumab: a review of its use in metastatic colorectal cancer.. Drugs, (28): [PMID:20481659] |
| 324. Madeo, Antonio A and Maggiolini, Marcello M.. (2010) Nuclear alternate estrogen receptor GPR30 mediates 17beta-estradiol-induced gene expression and migration in breast cancer-associated fibroblasts.. Cancer research, (15): [PMID:20551055] |
| 325. and Keating, Gillian M GM.. (2010) Spotlight on panitumumab in metastatic colorectal cancer.. BioDrugs : clinical immunotherapeutics, biopharmaceuticals and gene therapy, (1): [PMID:20623992] |
| 326. Vazquez-Martin, Alejandro A and 5 more authors.. (2011) Lapatinib, a dual HER1/HER2 tyrosine kinase inhibitor, augments basal cleavage of HER2 extracellular domain (ECD) to inhibit HER2-driven cancer cell growth.. Journal of cellular physiology, [PMID:20658522] |
| 327. Wang, Ying-Nai YN and 5 more authors.. (2010) COPI-mediated retrograde trafficking from the Golgi to the ER regulates EGFR nuclear transport.. Biochemical and biophysical research communications, (3): [PMID:20674546] |
| 328. Lu, Chafen C and 6 more authors.. (2010) Structural evidence for loose linkage between ligand binding and kinase activation in the epidermal growth factor receptor.. Molecular and cellular biology, [PMID:20837704] |
| 329. Hsu, Jung-Mao JM and 14 more authors.. (2011) Crosstalk between Arg 1175 methylation and Tyr 1173 phosphorylation negatively modulates EGFR-mediated ERK activation.. Nature cell biology, [PMID:21258366] |
| 330. Huang, Wei-Chien WC and 14 more authors.. (2011) Nuclear translocation of epidermal growth factor receptor by Akt-dependent phosphorylation enhances breast cancer-resistant protein expression in gefitinib-resistant cells.. The Journal of biological chemistry, (10): [PMID:21487020] |
| 331. Lupberger, Joachim J and 25 more authors.. (2011) EGFR and EphA2 are host factors for hepatitis C virus entry and possible targets for antiviral therapy.. Nature medicine, [PMID:21516087] |
| 332. Guo, Canhui C and Stark, George R GR.. (2011) FER tyrosine kinase (FER) overexpression mediates resistance to quinacrine through EGF-dependent activation of NF-kappaB.. Proceedings of the National Academy of Sciences of the United States of America, (10): [PMID:21518868] |
| 333. Pareja, F F and 18 more authors.. (2012) Deubiquitination of EGFR by Cezanne-1 contributes to cancer progression.. Oncogene, (25): [PMID:22179831] |
| 334. Tanno, Hidetaka H, Yamaguchi, Teppei T, Goto, Eiji E, Ishido, Satoshi S and Komada, Masayuki M.. (2012) The Ankrd 13 family of UIM-bearing proteins regulates EGF receptor endocytosis from the plasma membrane.. Molecular biology of the cell, [PMID:22298428] |
| 335. Takeshita, Kohei K and 8 more authors.. (2012) Structural flexibility regulates phosphopeptide-binding activity of the tyrosine kinase binding domain of Cbl-c.. Journal of biochemistry, [PMID:22888118] |
| 336. Zhou, Houjiang H and 6 more authors.. (2013) Toward a comprehensive characterization of a human cancer cell phosphoproteome.. Journal of proteome research, (4): [PMID:23186163] |
| 337. Ceccon, Monica M, Mologni, Luca L, Bisson, William W, Scapozza, Leonardo L and Gambacorti-Passerini, Carlo C.. (2013) Crizotinib-resistant NPM-ALK mutants confer differential sensitivity to unrelated Alk inhibitors.. Molecular cancer research : MCR, [PMID:23239810] |
| 338. Smith, Christopher J CJ, Berry, Donna M DM and McGlade, C Jane CJ.. (2013) The E3 ubiquitin ligases RNF126 and Rabring7 regulate endosomal sorting of the epidermal growth factor receptor.. Journal of cell science, (15): [PMID:23418353] |
| 339. Midgley, Adam C AC and 6 more authors.. (2013) Transforming growth factor-β1 (TGF-β1)-stimulated fibroblast to myofibroblast differentiation is mediated by hyaluronan (HA)-facilitated epidermal growth factor receptor (EGFR) and CD44 co-localization in lipid rafts.. The Journal of biological chemistry, (24): [PMID:23589287] |
| 340. Hong, Shiao-Ya SY, Shih, Yi-Ping YP, Li, Tianhong T, Carraway, Kermit L KL and Lo, Su Hao SH.. (2013) CTEN prolongs signaling by EGFR through reducing its ligand-induced degradation.. Cancer research, (15): [PMID:23774213] |
| 341. Lin, Changsheng C and 8 more authors.. (2014) Structural basis for activation of trimeric Gi proteins by multiple growth factor receptors via GIV/Girdin.. Molecular biology of the cell, (5): [PMID:25187647] |
| 342. Lin, Xiaofeng X and 15 more authors.. (2014) EGFR phosphorylates and inhibits lung tumor suppressor GPRC5A in lung cancer.. Molecular cancer, (14): [PMID:25311788] |
| 343. Mozzi, Alessandra A and 13 more authors.. (2015) NEU3 activity enhances EGFR activation without affecting EGFR expression and acts on its sialylation levels.. Glycobiology, [PMID:25922362] |
| 344. Kabe, Yasuaki Y and 20 more authors.. (2016) Haem-dependent dimerization of PGRMC1/Sigma-2 receptor facilitates cancer proliferation and chemoresistance.. Nature communications, (18): [PMID:26988023] |
| 345. Runkle, Kristin B KB and 6 more authors.. (2016) Inhibition of DHHC20-Mediated EGFR Palmitoylation Creates a Dependence on EGFR Signaling.. Molecular cell, (5): [PMID:27153536] |
| 346. Yang, Yifei Y and 7 more authors.. (2017) Discovery of imidazopyridine derivatives as novel c-Met kinase inhibitors: Synthesis, SAR study, and biological activity.. Bioorganic chemistry, [PMID:28043720] |
| 347. Haley, J D JD and Waterfield, M D MD.. (1991) Contributory effects of de novo transcription and premature transcript termination in the regulation of human epidermal growth factor receptor proto-oncogene RNA synthesis.. The Journal of biological chemistry, (25): [PMID:1988448] |
| 348. Ishii, S S and 5 more authors.. (1985) Characterization and sequence of the promoter region of the human epidermal growth factor receptor gene.. Proceedings of the National Academy of Sciences of the United States of America, [PMID:2991899] |
| 349. Simmen, F A FA and 5 more authors.. (1984) Isolation of an evolutionarily conserved epidermal growth factor receptor cDNA from human A431 carcinoma cells.. Biochemical and biophysical research communications, (15): [PMID:6093780] |
| 350. Lin, C R CR and 8 more authors.. (1984) Expression cloning of human EGF receptor complementary DNA: gene amplification and three related messenger RNA products in A431 cells.. Science (New York, N.Y.), (25): [PMID:6326261] |
| 351. Galcheva-Gargova, Z Z and 5 more authors.. (1996) Binding of zinc finger protein ZPR1 to the epidermal growth factor receptor.. Science (New York, N.Y.), (21): [PMID:8650580] |
| 352. Komurasaki, T T, Toyoda, H H, Uchida, D D and Morimoto, S S.. (1997) Epiregulin binds to epidermal growth factor receptor and ErbB-4 and induces tyrosine phosphorylation of epidermal growth factor receptor, ErbB-2, ErbB-3 and ErbB-4.. Oncogene, (4): [PMID:9419975] |
| 353. Abe, Y Y and 5 more authors.. (1998) Disulfide bond structure of human epidermal growth factor receptor.. The Journal of biological chemistry, (1): [PMID:9556602] |
| 354. Arcaro, A A and 5 more authors.. (2000) Class II phosphoinositide 3-kinases are downstream targets of activated polypeptide growth factor receptors.. Molecular and cellular biology, [PMID:10805725] |
| 355. Reiter, J L JL and 14 more authors.. (2001) Comparative genomic sequence analysis and isolation of human and mouse alternative EGFR transcripts encoding truncated receptor isoforms.. Genomics, (1): [PMID:11161793] |
| 356. Li, Y Y and 7 more authors.. (2001) The epidermal growth factor receptor regulates interaction of the human DF3/MUC1 carcinoma antigen with c-Src and beta-catenin.. The Journal of biological chemistry, (21): [PMID:11483589] |
| 357. Albanell, J J and 11 more authors.. (2001) Activated extracellular signal-regulated kinases: association with epidermal growth factor receptor/transforming growth factor alpha expression in head and neck squamous carcinoma and inhibition by anti-epidermal growth factor receptor treatments.. Cancer research, (1): [PMID:11522647] |
| 358. Thomas R Burkard,Melanie Planyavsky,Ines Kaupe,Florian P Breitwieser,Tilmann Bürckstümmer,Keiryn L Bennett,Giulio Superti-Furga,Jacques Colinge. (2011-01-29) Initial characterization of the human central proteome.. BMC systems biology, 5 (17-17). [PMID:21269460] |
| 359. R Cipriano,B L Bryson,K L S Miskimen,C A Bartel,W Hernandez-Sanchez,R C Bruntz,S A Scott,C W Lindsley,H A Brown,M W Jackson. (2013-08-06) Hyperactivation of EGFR and downstream effector phospholipase D1 by oncogenic FAM83B.. Oncogene, 33 ((25)): (3298-3306). [PMID:23912460] |